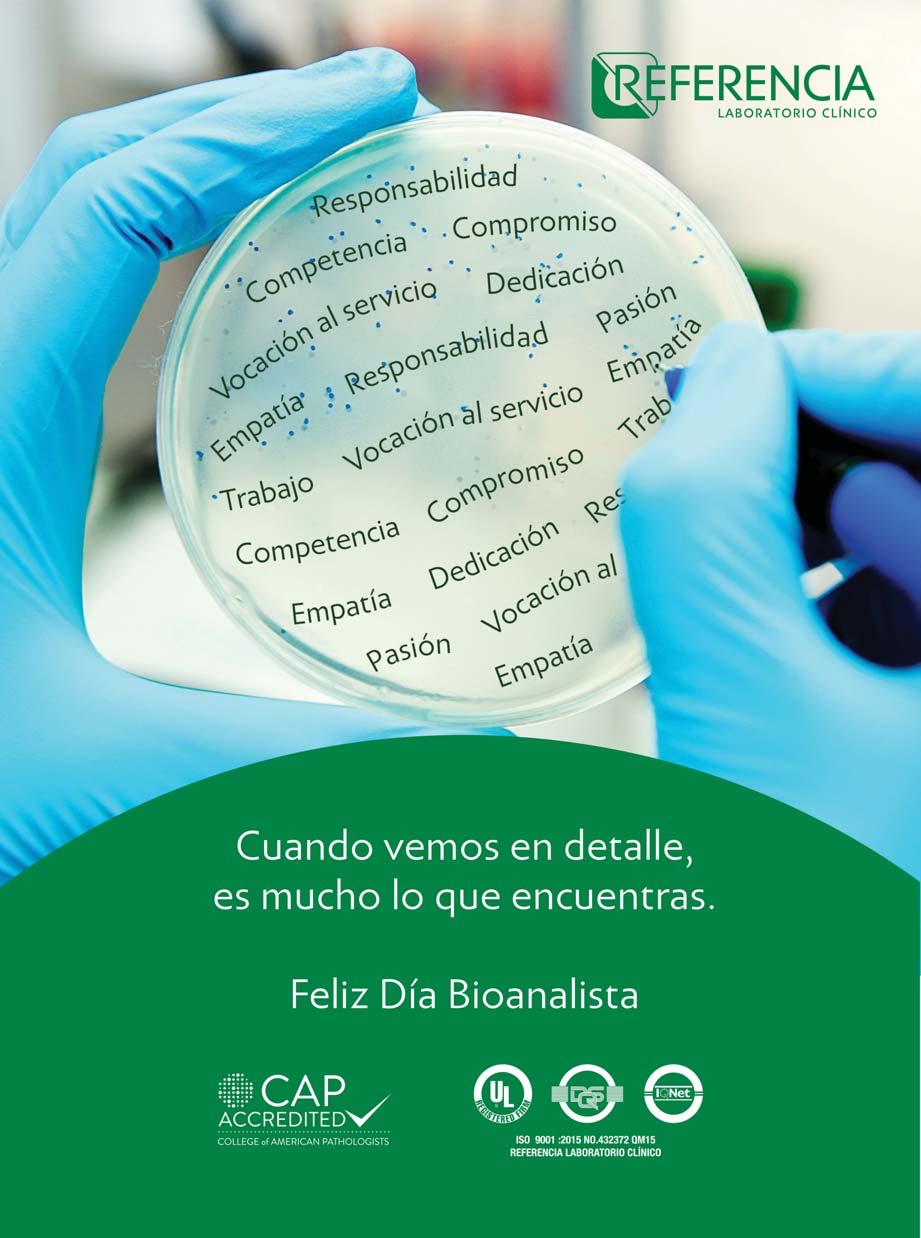

JUEVES
9 mayo 2024
N°6814, Año 23
Santo Domingo, RD www.diariolibre.com
1LECTORÍA IMPRESA Y DIGITAL #

Y ADEMÁS...
b Fuerza del Pueblo pide a la JCE inscribir a Rafael Paz para diputado. P8
b Penn: El debate presidencial no afectó la intención de voto. P12
b Minerd y ADP seguirán el diálogo luego de las elecciones. P14
b República Dominicana expuesta a riesgos naturales sin mucha protección financiera. P17
PROSTITUCIÓN DE CRIOLLAS EN ESPAÑA b


Abinader denuncia que crisis en Haití golpea el presupuesto dominicano
b Queja se produce ante la comunidad internacional b Fue premiado por la Conferencia de Las Américas b Asegura Poder Ejecutivo no influirá en las elecciones

p WASHINGTON. El presidente dominicano Luis Abinader recibió ayer un reconocimiento de manos de Andres Gluski y Susan Segal, presidente de la junta directiva del Council of the Americas y CEO del mismo consejo, respectivamente, convirtiéndose en el primer mandatario quisqueyano en recibir el premio Chairman’s Award for Leadership in the Americas que otorga dicho organismo. b P4


FUENTE EXTERNA ELLY DE LA CRUZ IMPRESIONA b P30
P16

MIRADA LIBRE
Migrantes climáticos
Cuando hablamos del cambio climático solemos confundir el concepto con problemas medioambientales y no entendemos que, aunque son temas hermanos, no son lo mismo, más bien, son algo así como los dos cuernos de una cabeza, vinculados, pero autónomos.
Y en esa falla conceptual se comente el catastrófico error de pasarle por encima a desafíos que son esenciales para nuestro futuro, pero que son muy complejos de ver a corto plazo, porque no resultan fáciles de “vender”. Es una realidad que ahora mismo la lucha ambiental se circunscribe a defender las Dunas de Baní, pelear contra la basura, luchar contra los incendios forestales y proteger las especies y zonas en peligro. Todos esos puntos son importantes, pero de nada vale delinear estrategias sobre ellos sino vemos las soluciones a largo plazo y miramos los factores macro que serán determinantes en su evolución.
Un ejemplo de ello es la migración climática, que no es otra cosa que el desplazamiento de la población por los problemas que generan el cambio climático y la sobrexplotación de los recursos naturales.
Ayer publicamos en Diario Libre una información dada por el Banco Mundial en la cual alerta que para el 2050 el Distrito Nacional, y otras ciudades cabeceras, será un “punto receptor” de migrantes internos y de origen haitiano, que abandonarán los campos para ubicarse en las zonas urbanas por los problemas extremos que traerá el cambio climático, como las sequías sostenidas, las lluvias excesivas y la lenta regeneración de los recursos naturales. Pensarán que no hay que ocuparse de ello porque es en el 2050, pero sepan que el planeta y sus recursos no se regeneran con la velocidad o los cortos periodos de tiempo que rigen la vida humana. Si desde ahora ese tema no comienza a ser atendido y se establecen programas de regeneración, planes de mitigación para las sequías y estrategias de manejo para las inundaciones, lo cierto es que heredaremos a nuestros nietos un país incapaz de salvar su ruralía. Ese escenario será terrible, porque no todos cabemos en la ciudad y no habrá cama para tanta gente. bmorales@diariolibre.com

Noticiero Poteleche


Memoria viva
Guillermo Piña-Contreras
¿Hubo una revolución el 24 de abril del 65?
Como los militares que derrocaron al gobierno de facto presidido por Donald Reid Cabral no lograron restablecer, como era su objetivo, “la Constitución de 1963” y al depuesto presidente Juan Bosch, no son pocos los que consideran que los “constitucionalistas” fracasaron en el enfrentamiento armado con los militares del Centro de Enseñanza de las Fuerzas Armadas (CEFA), de la base aérea de San Isidro que se oponían a la reposición de Bosch. Ese conflicto bélico que parecía favorecer a los “constitucionalistas” fue interrumpido tres días más tarde, el 28 de abril, por una intervención militar de Estados Unidos, apoyada por la Organización de Estados Americanos (OEA), para evitar una segunda Cuba en sus narices. Ese día los militares “constitucionalistas”, que lideraba Francis Caamaño, tuvieron la certeza de que habían perdido la guerra, pero también eran conscientes de que habían comenzado el cambio que el presidente Bosch no pudo llegar a concretar en los pocos meses que duró su gobierno en 1963. La sangre vertida entre abril y septiembre de 1965 venía a completar la de aquello jóvenes caídos entre la primavera y el otoño de 1961. A la estela de sangre dejada por la familia Trujillo y secuaces, al huir de República Dominicana, le faltaba más, como diría con sus versos Pedro Mir: “Y sacando los héroes de la tumba/ habrá sangre de nuevo en el país. /Habrá sangre de nuevo en el país”. Y la hubo. Unos 3 mil muertos, se dice, entre la primavera y el otoño de 1965. Los jóvenes constitucionalistas se enfrentaron al ejército más poderoso del mundo; no vencieron; pero se perdió el miedo que la dictadura de Trujillo había logrado infundir en los dominicanos. Se me ocurre pensar, a menudo, que los militares y jóvenes constitucionalistas que no entendieron que habían perdido la guerra, incluido el propio líder militar de Abril del 65, cayeron en las calles de la Capital o en los montes de República Dominicana víctimas de la represión desatada por el gobierno de García-Godoy, porque no tenían miedo de enfrentarse al gobierno de la Pax americana que las fuerzas de ocupación, con el aval de la OEA, habían dejado instalado en República Dominicana en septiembre de 1965 y, al año siguiente, al de Joaquín Balaguer.
El 3 de septiembre de 1965 se firmó el Acta institucional que puso fin a la guerra civil dejando a Héctor García-Godoy como presidente provisional hasta la toma de posesión del ganador de los comicios del 1 de julio de 1966. Ese mismo día, el país había dado al traste con la dictadura de Trujillo. El cambio no se produjo el 18 de noviembre de 1961 cuando Ramfis, familia y acólitos huyeron tras asesinar a los conjurados del complot que ajustició a Rafael Trujillo. Al Francis Caamaño poner su firma en el Acta institucional ponía fin a cuatro meses de guerra civil, pero, a partir de ese histórico día, República Dominicana es otra. Es la República Dominicana de hoy, a pesar de que la Pax americana trazó un rumbo diferente al que aspiraban darle los militares y jóvenes constitucionalistas. Hubo revolución en las artes, la literatura, la política y, en abril de 1965, se completó el ciclo que habían iniciado los que acabaron, en 1961, con la dictadura de Trujillo. Para verificar que hubo revolución basta mirar hacia atrás.

Jueves, 9 de mayo de 2024 DiarioLibre. 2 /
FUENTE EXTERNA
Benjamín Morales Meléndez

Jueves, 9 de mayo de 2024 DiarioLibre. / 3
NOTICIAS
El tiempo hoy en SD
Chubasco
Máxima 31
Mínima 23
EN OTRAS CIUDADES
Nueva York 22/11 Chu
Miami 30/25 Nub
Orlando 36/24 Sol
San Juan 30/25 Llu
Madrid 27/13 Nub
Abinader: crisis en Haití drena recursos de dominicanos
b El presidente garantizó la no intervención en las elecciones del próximo 19 de mayo b La Conferencia de Las Américas le entregó el premio al Liderazgo de las Américas
B. Rosario / L. Almonte
WASHINGTON. El presidente Luis Abinader se quejó ante la comunidad internacional del peso económico que significa la crisis haitiana para el presupuesto de la República Dominicana y aseguró que la falta de un mandatario en Haití, que haga cumplir la ley, ha drenado recursos necesarios para el desarrollo de los dominicanos. El mandatario recibió en Washington, Estados Unidos, el premio Chairman’s Award for Leadership in the Americas por parte de la Conferencia de las Américas.
Aprovechó el escenario para resaltar que uno de los retos más difíciles que ha enfrentado la República Dominicana “ha sido consecuencia del descalabro político, económico y social de la nación haitiana, desde la muerte del presidente Jovenel Moïse”.
Abinader manifestó que, desde el magnicidio, RD ha asumido una carga desproporcionada, sin colaboración de una contraparte efectiva que pueda imponer en su territorio el imperio de la ley. “Esto ha drenado recursos necesarios para el desarrollo dominicano”, indicó. No obstante, reconoció la
respuesta que finalmente ha dado la comunidad de países del mundo con el envío de una fuerza de paz hacia Haití.
“La instalación del Consejo Presidencial de Transición en Haití y la inminente llegada de la Misión Multinacional de Apoyo a la Seguridad en ese país nos alientan a pensar que
Primer dominicano premiado
4
Esta fue la primera vez que un presidente o funcionario de la República Dominicana recibe el premio al Liderazgo de las Américas, el cual reconoce a las personas que han hecho contribuciones positivas a la gobernabilidad democrática en América Latina y el Caribe. Este año, la Conferencia de Las Américas está enfocada en mejorar la promoción de América Latina para la inversión, el comercio y el compromiso económico. “Creemos que el presidente lo ha hecho de manera efectiva, ha reducido la corrupción, ha construido una economía más fuerte y, por supuesto, las relaciones entre Estados Unidos y la República Dominicana son muy fuertes, saludables y están creciendo”, dijo Eric Farnsworth, vicepresidente de este Consejo.

VAYA PERLA “Nuestras tropas desplegadas en la frontera tienen todo el equipamiento y la cantidad de hombres necesarios para el cumplimiento de nuestra sagrada misión”
Carlos A. Fernández
Comandante Gral. Ejército RD
EL ESPÍA
Depende del cristal con que se mira
A escasos dos días de vencer el plazo para la publicación de las encuestas electorales, las mediciones se han quintuplicado con números favorables para cada parcela política. Las hay que dan un triunfo arrollador al reelecionista Luis Abi-
nader, otras que colocan por encima a Leonel Fernández o que apuntan a una segunda vuelta electoral. Lo cierto es que las encuestas políticas siempre serán dependiendo del cristal con que se miran, ya sea blanco, verde o morado.

se ha abierto un camino hacia el restablecimiento de la paz, la seguridad y la democracia en Haití”, expresó.
Inversión
El presidente dominicano también hizo un llamado sobre la necesidad de llevar recursos para reconstruir a Haití y asegurarse de que esa nación tenga futuro. “Es importante decir que, simultáneamente con la pacificación de Haití, el país requerirá un plan de inversión de envergadura para que el pueblo haitiano pueda tener acceso a lo esencial: empleo, salud y educación”, manifestó.
Agradeció a los gobiernos de Estados Unidos, Canadá, Kenia y a los miembros del CARICOM. Además, al Consejo de Seguridad y al secretario general de la Organización de las Naciones Unidas y a la Organización de Estados Americanos.
Elecciones
El presidente Abinader garantizó en su discurso la no intervención del Poder Ejecutivo en el proceso electoral del 19 de mayo, cuando serán elegidos los diputados, senadores y el presidente de la República.
“Quiero ser categórico frente a ustedes, como partido compuesto por demócratas convencidos, puedo asegurarles la plena imparcialidad del Poder Ejecutivo para que dicho certamen sea libre, justo y transparente” afirmó.
El mandatario resaltó las cualidades de la democracia dominicana y el hecho de que se han realizado 12 elecciones desde el primer gobierno del Partido Revolucionario Dominicano (PRD), en el año 1978.
Dijo que, “en consonancia con esto, la Junta Central Electoral (JCE) ha abierto las puertas a todos los observadores internacionales en el acompaña-
miento del proceso, asegurando así la integridad” de las elecciones.
Abinader consideró que el galardón que recibió se debe “al notable desempeño que en los últimos años ha mostrado República Dominicana por el mayor compromiso” de su gobierno con los valores democráticos, el crecimiento económico, el respeto a las libertades y derechos ciudadanos.
“Este reconocimiento implica una mayor responsabilidad con la gobernanza democrática, y me comprometo frente a ustedes a continuar profundizándola”, acotó. Y destacó que es la primera vez que esta organización reconoce a una economía en desarrollo del Caribe. b

4 / Jueves, 9 de mayo de 2024 DiarioLibre.
L FUENTE EXTERNA
0 El presidente Luis Abinader habló tras recibir el premio al Liderazgo de Las Américas.

Jueves, 9 de mayo de 2024 DiarioLibre. / 5
La velada
El mandatario compartió con la prensa previo a su reconocimiento
El presidente Abinader está contento
WASHINGTON, EE,UU. Los invitados estaban ya en el restaurante cuando llegó acompañado de su esposa, Raquel, los ministros Pável Isa y Jochi Vicente, Daniel García Archibald, director de prensa de la Presidencia; de su equipo de seguridad, reforzado por el Servicio Secreto norteamericano, y de la embajadora Sonia Guzmán.
Apenas una hora antes había aterrizado en uno de los aeropuertos en las afueras de la capital norteamericana, en vuelo directo desde Santo Domingo. La esposa, vestida de blanco, y la embajadora, de negro.
Elegantes ambas.
Ambiente distendido, te-
mas serios salpicados de bromas y un presidente relajado, aumentada su tranquilidad por los números positivos de las últimas encuestas electorales.
El restaurante El Cielo, con una estrella Michelin como señal de la calidad de sus fogones, estaba reservado solo para el presidente Luis Abinader y sus invitados, un pequeño grupo de periodistas de diferentes medios dominicanos.
Menos mal que doña Raquel está aquí, porque de lo contrario cenaríamos un par de “kipes” y nada más dada la austeridad del presidente, bromeó uno de los invitados, seguido de la carcajada colectiva. Quiero darles la bienve-

nida a todos y agradecerles que aceptaran mi invitación.
Esta es una invitación personal de Raquel y mía.
La elección del restaurante, de decorado y servicio impecables, y con una propuesta culinaria atractiva, no fue casual.
Este restaurante me lo sugirió una hija que pasó algún tiempo aquí en Washington. Hay otro en Miami.
Lo que hablemos no es

para ser publicado. Excepto un tema: ha estado lloviendo fuertemente en gran parte del país y este mayo será muy húmedo. Hemos acordado una serie de medidas para ir en socorro de las personas afectadas por las lluvias. Me preocupa esa situación y hablamos con la Junta Central Electoral, para que se entienda que las labores de socorro nada tienen que ver con mi campaña.
Entre risas, bocados y tragos la noche avanzaba. Los platos colombianos tradicionales, elevados al cielo por el chef Juan Manuel Barrientos, provocan chuparse los dedos. La comida hace honor al nombre del restaurante.
¿Las encuestas? El presidente da sus números, pero todo lo que se habla es “off the record”.
—¿Y adónde irá Vicente en un nuevo gobierno?”
Eso sí que está resuelto, lo hablamos ya en el avión. Lo vamos a enviar a Correos.
Risas a todo lo largo y ancho de la mesa rectangular que ocupa todo el comedor del restaurante.
El intercambio de opiniones sobre el primer debate entre los aspirantes a la presidencia no podía faltar. Los comentarios de Abinader se quedan fuera de récord, pero coinciden plenamente con el análisis que habían hecho los periodistas invitados cuando se quedaron varados por un par de horas en el aeropuerto de Miami, por problemas mecánicos en el avión de American Airlines que los trasladaría a Washington. Educación, salud, la oposición, las elecciones, la posible composición del próximo Congreso y tantos otros puntos que alimentan cotilleos, a las redes y las páginas de los periódicos asoman en la mesa. Las opiniones fluyen al mismo


ritmo que el primer vino, un Txakoli del País Vasco. Toda una sorpresa de atisbos cítricos, manzanas verdes y peras. Antes de unas codornices adobadas con toques de especies mágicas, sirven el próximo caldo: un Flor de Pingus espectacular, a la par en calidad con el último plato fuerte, lonjas de bisonte a las que una salsa, celestial tenía que ser, realza. El presidente está contento. Estaba programado a ser el primer mandatario dominicano en recibir el Chairman’s Award for Leadership in the Americas al día siguiente en una ceremonia solemne en la sede de la Organización de Estados Americanos (OEA), razón de su viaje.
Luego hablaría a la comunidad empresarial en Washington. Se echa de menos la presencia del ministro de Rela-
ciones Exteriores, Roberto Álvarez Gil. Le ha tocado quedarse en el hotel dando un último vistazo al discurso que pronunciaría en la OEA en la 54 Conferencia sobre las Américas.
Los postres transportan a la mesa el embeleso de las frutas exóticas de los bosques colombianos, acompañados de una copa de ron dominicano, un Brugal 1888. A esos dulces suaves, tropicales, les viene bien la compañía caribeña. El presidente está contento y se marcha con la sonrisa en los labios. Le aguarda un día de júbilo y de reuniones de trabajo. En la tarde del miércoles volvería a Santo Domingo, a los problemas y a la campaña electoral. ¿Seguirá contento? b ADC
Reportaje completo en diariolibre.com
Noticias OpiniónRevistaDeportes Jueves, 9 de mayo de 2024 DiarioLibre. 6 /
up
FUENTE EXTERNA
Carlos Felipe Jaramillo, Ajay Banga y Coralix Gevers, del BM.
FUENTE EXTERNA
El presidente Luis Abinader junto a los ministros de Hacienda y Economía, Jochi Vicente y Pável Isa, respectivamente.
FUENTE EXTERNA
Luis Abinader y Ajay Banga, presidente del Banco Mundial.

Jueves, 9 de mayo de 2024 DiarioLibre. / 7
FP apelará exclusión y pedirá a la Junta inscribir a Paz
JCE pide a los partidos actuar con prudencia y da garantías

Leonel calificó de “injusta e inconstitucional” la medida
SD. La Fuerza del Pueblo (FP) informó ayer que recurrirá la resolución 35-2024 de la Junta Central Electoral (JCE), la cual deja fuera de la boleta a Rafael Paz como uno de los candidatos a diputados en la Circunscripción 1 del Distrito Nacional.
Javier Ubiera, delegado suplente de la FP en la JCE, informó que el partido apelará la medida, porque “desconoce la renuncia de una de las candidatas” y la incluye en la boleta. Según Ubiera, horas antes de darse a conocer la resolución, Katiuska Morel Alcántara renunció a su candidatura. Sin embargo, pasadas las 8:30 de la noche del ayer miércoles, la FP no había depositado ninguna instancia.
“La propia resolución de la Junta desconoce una renuncia de una de las candidatas y la incluye en la boleta habiendo renunciado horas antes de la decisión y es algo que nos llama la atención de porqué la incluyen en la boleta”, dijo el dirigente. En un mensaje en X, Leonel Fernández, candidato presidencial de la FP, calificó de “injustas e inconstitucionales” las disposiciones que excluyen a Paz. El exmandatario se refirió a los dispositivos del Tribunal Superior Electoral (TSE) y de JCE, que sacan a Paz de la boleta y entran a otros candidatos. El pasado martes, el
órgano electoral emitió la lista de los seis candidatos a diputados de la FP en la Circunscripción 1 de la capital, omitiendo a Paz.
Cómo quedó La boleta quedó así: Andy Roberto Morales Rivera, Francisco José Guillen, Roberto Enmanuel Martínez Amparo, Selinée Méndez, Rosa Margarita Feliciano Rodríguez y Katiuska Morel Alcántara.
La JCE informó que adoptó la decisión “para no dilatar más las actividades del calendario electoral, específicamente la impresión de la boleta electoral de la circunscripción 1 del Distrito Nacional, la cual, para esta fecha, tenía que estar impresa”. El pasado viernes 3 de mayo, la FP depositó una lista en que incluía a Paz, pero dejaba fuera a Andy Morales, quien, inmediatamente, dejó saber que no renunciaría a su candidatura.b
La travesía de Rafael Paz
El miércoles, Rafael Paz usó su cuenta de X para desahogarse: “Soy honesto cuando digo que prefiero sufrir el látigo de la injusticia sobre mis espaldas, que el peso y la indignidad en mi corazón de comulgar con lo mal hecho”. Entre otros puntos, expresó que “no renunciaré a mis convicciones y no me cansaré. Para mí, la política es parte de un propósito de vida”.
Dice organizaciones deben enfocarse en la democracia y los valores
Ycell Suero
SD. Román Jáquez Liranzo, presidente de la Junta Central Electoral (JCE), hizo un llamado a los partidos políticos para que promuevan un mensaje de “civismo y prudencia” entre sus seguidores, instándolos a votar en las venideras elecciones presidenciales y congresuales.
“Ese debe ser el mensaje a sus seguidores, a sus simpatizantes y a sus votantes. Cualquier otro mensaje que no sea este, y el llamado masivo a votar, no es un mensaje correcto”, señaló el presidente del órgano electoral.
Citó a Juan Pablo Duarte al exponer que “la política no es una especulación, es una ciencia, la más pura, la más digna”.
En su participación en el almuerzo de la Cámara Americana de Comercio de la República Dominicana (AMCHAMDR), expuso que, como sistema político electoral, se debe seguir apostando a la institucionalidad democrática y al fortalecimiento del desarrollo nacional, ya que, de no hacerlo, se estaría tambaleando la estabilidad del país.

Exhortó a los partidos a enfocarse en la democracia, principios y valores para no “tener que poner la barba en remojo”.
“A 11 días de las elecciones del 19 de mayo, este Pleno de la JCE reitera a todo el país y el exterior la garantía de una elecciones íntegras, cívicas, seguras, pacíficas, dignas, transparentes y justas. La organización del proceso electoral marcha viento en popa y a toda
vela”, expresó Jáquez Liranzo.
Policía Militar Electoral
En momentos en que los partidos políticos de oposición esperan respuestas a la solicitud de que sea destituido el director de la Policía Militar Electoral (PME), el mayor general José Otaño Jiménez, el presidente de la JCE aseguró que el Pleno es quien dirige
las acciones de ese cuerpo. “El pleno de la JCE reitera que constitucional y legalmente es la (el) que dirige, manda e instruye a través de todo el territorio nacional al jefe de la Policía Militar Electoral y a los 60,000 hombres y mujeres que tendrán a su cargo la indicada función apegada de manera irrestricta y categórica a nuestras resoluciones y a las leyes que rigen el desarrollo del proceso electoral”, precisó.
Jáquez Liranzo explicó que el pleno aprobó un plan para el correcto reforzamiento de la seguridad durante las elecciones del 19 de mayo. Los recintos electorales estarán coordinados por un oficial superior junto a oficiales subalternos y dos miembros de la Policía Militar por cada colegio a nivel nacional. Como parte de su ponencia durante el almuerzo, el presidente de la JCE, enfatizó que los trabajos de la PME se dividirán en tres grupos, el primero estará encargado de la cadena de custodio del proceso, el segundo la protección y vigilancia en el perímetro de los recintos y el tercero con los auxiliares del Ministerio Público Electoral. b
Candidatos opositores intensifican las actividades proselitistas en recta final
Solo faltan siete días para que inicie la veda electoral; entra en vigencia el 16 de mayo
Stephanie Hilario Soto
SD. Los partidos de la oposición intensifican actividades proselitistas cuando solo faltan siete días para que inicie la veda electoral, que entra en vigencia el 16 de mayo.
El candidato presidencial del partido Fuerza del Pueblo (FP) y organizaciones aliadas, Leonel Fernández, recorrerá parte del Cibao y varias provincias de la región sur.
Fernández encabezará este jueves, desde las 3:00 de la tarde, una caravana en San José de Ocoa. A las 5:00 de la tarde, se trasla-
dará a Azua.
Mañana, viernes, recorrerá las calles de Barahona, Independencia y Bahoruco. Mientras, el sábado, visitará las provincias del Este y, el domingo, recorrerá La Vega y Santiago.
Recorrido de Abel Por otro lado, el Partido de la Liberación Dominicana (PLD) y su candidato presidencial, Abel Martínez, harán una marcha-caravana que abarcará las provincias, Barahona, Bahoruco e Independencia. Para las 10:30 de la mañana de hoy la caravana iniciará en Vicente Noble, Barahona y pasará a Tamayo, Galván y Neyba, entre otros municipios de la provincia Bahoruco. Desde ahí seguirá hacia Duvergé, provincia Independencia.

El viernes, Martínez se trasladará a la región Este a las provincias Hato Mayor, El Seibo, La Romana y San Pedro de Macorís.
Miguel Vargas
El candidato presidencial perredeísta, Miguel Vargas, y su compañero de boleta, Joel Díaz, tendrán este jueUna marcha de Fuerza del Pueblo.
ves un encuentro del Frente Magisterial con Vargas y Díaz, en la Casa Nacional del PRD, en la capital. El viernes harán un recorrido por la circunscripción dos del Distrito Nacional, mientras que el sábado irán a Azua y San José de Ocoa. El domingo viajarán a San Cristóbal. b
Noticias OpiniónRevistaDeportes Jueves, 9 de mayo de 2024 DiarioLibre. 8 /
FUENTE EXTERNA
Rafael Paz buscaba entrar a la Cámara de Diputados.
4
NEAL CRUZ
Román Jáquez Liranzo, presidente de la JCE.
SAMIL MATEO/DL

Jueves, 9 de mayo de 2024 DiarioLibre. / 9
Guillermo o Vinicio ¿Quién es el candidato a senador de Abinader?
La imagen del presidente es usada para apalancar las campañas de Moreno y Castillo
Balbiery Rosario
SANTO DOMINGO. El candidato a la senaduría del Distrito Nacional por el partido Fuerza Nacional Progresista (FNP), Vinicio Castillo Semán, ha desplegado una campaña publicitaria en vallas y medios impresos y digitales en la que se le ve junto al presidente Luis Abinader tanto o más que el propio Guillermo Moreno, quien es el candidato del Partido Revolucionario Moderno (PRM).
Castillo explicó este extraño fenómeno en el Cafecito Político de Diario Libre. Lo primero es que el PRM, la FNP y el Partido Reformista Social Cristiano
(PRSC) van aliados en el nivel presidencial y llevan a un candidato común: Luis Abinader. Por lo tanto, Abinader va en la boleta de los tres partidos.
Sin embargo, Moreno no está incluido en esa unión, de modo que el PRSC y la FNP llevan a su propio candidato, que es Vinicio Castillo Semán.
“Lo que pasa es que yo soy el candidato del PRSC en la alianza con la FNP, que lleva el presidente Abinader de candidato presidencial, por eso ves la promoción”, indica Castillo. El político y abogado está seguro de que hay mucha gente que simpatiza por Abinader, pero no va a vo-
Conflicto en la frontera
4El conflicto entre el gobierno dominicano y los constructores de un canal en el río Dajabón, del lado haitiano, ha llegado a un punto de confrontación que podría escalar a un ataque armado, según proyecta Vinicio Castillo. Considera que a las bandas armadas que controlan a Haití les conviene generar un enfrentamiento antes de que se pueda materializar la intervención militar que organiza la comunidad internacional. El político advierte que “uno de los blancos que pueden usar es un ataque sobre la toma de agua La Vigía”, obra que RD ha usado para captar el agua antes de que pueda llegar a la boca del canal.

tar por Moreno por cuestiones ideológicas e históricas. Se recuerda que Moreno quiso investigar a Joaquín Balaguer cuando fue fiscal del Distrito Nacional por la muerte del periodista Orlando Martínez.
“Guillermo ha sido un hombre de izquierda, yo he sido un hombre de derecha. Mi partido y el Reformista ideológicamente estamos muy definidos en nuestros temas y Guillermo representa un sector de la sociedad diferente al electorado nuestro”, señala Castillo.
Cambio de bando
La FNP estuvo aliada durante las últimas dos décadas al Partido de Liberación Dominicana (PLD) y, en las últimas elecciones, año 2020, a Leonel Fernández y su Fuerza del Pueblo. Pero en 2024 se ha girado hacia el PRM y Luis Abinader. Castillo Semán asegura
que este cambio de bando se debió al acuerdo entre Fernández y Danilo Medina. Cuenta que en el 2020 luchó junto a Fernández contra el Gobierno de Danilo Medina, por lo que hoy no puede participar aliado él. “En el 2020 hicimos campaña contra Danilo Medina y su gobierno. El presidente Fernández dijo que era el Trujillo del XXI, que trataba de instalar una dictadura en el país. Dijo que el PLD ya no existía, porque los principios éticos habían desaparecido. Todo eso al lado nuestro… Mal podríamos nosotros, por una lealtad del doctor Fernández, aparecernos frente al mismo electorado diciendo que ese mismo grupo que nosotros desalojamos del poder por ser lo peor ahora son nuestros aliados. Es un tema de coherencia mínima y ética que, tristemente, nos llevó a una separación”, narra el candidato. b
Gabinete de Política Social acatará mandato de la Junta Central Electoral
El coordinador del organismo, Tony Peña Guaba dice cumplen con la ley
SD. El coordinador del Gabinete de Política Social Tony Peña, aclaró que las jornadas y operativos que realiza cada semana esa institución se encuentran dentro de las responsabilidades y compromisos contemplados en el Plan Operativo Anual (POA) de esa entidad, por lo que no pueden considerarse como extraordinarias.
No obstante, Peña señaló
que, en aras de contribuir con la democracia y la transparencia que, afirma, le caracteriza al frente del Gabinete de Política Social, acatará completamente el llamado de la Junta Central Electoral (JCE) de suspender las jornadas sociales hasta que pasen las elecciones del próximo 19 de mayo.
“Aunque respetaremos lo dispuesto por la JCE y no ejecutaremos ninguna de las actividades programadas en el POA, es importante aclarar que las ejecutorias que se realizan en el Gabinete de Política Social

CUADERNO DE POLÍTICA
Fuerza Colorá respalda a Omar
SD. El presidente del movimiento Fuerza Colorá, Manuel Alsina de Castro, anunció su respaldo a la candidatura a senador por la Fuerza del Pueblo, en el Distrito Nacional de Omar Fernández. Dijo que es necesario “abrir puertas a la juventud dominicana que está preparada”. “Anunciamos nuestro apoyo a la candidatura de Omar, porque ningún reformista debe estar de acuerdo en que Guillermo Moreno sea senador”, manifestó.
RD lista para una mujer presidenta

SD. El conversatorio «Mujeres Exitosas: Creando Oportunidades con Equidad» reunió a empresarias de diversos sectores para discutir el impacto económico y social de las mujeres En un encuentro organizado por la Confederación Dominicana de la Micro, Mediana y Pequeña Empresa (Codopyme), la vicepresidenta de República Dominicana, Raquel Peña, afirmó que República Dominicana ya está preparada para escoger a una mujer presidenta.
Olgo Fernández acusa gobierno PRM de indolente e indiferente
SD. El Partido de la Liberación Dominicana (PLD) deploró la indiferencia con la que dicen las autoridades están tratando el caso de las inundaciones urbanas y desbordamiento de ríos, cañadas y arroyos fruto de los aguaceros que se registran en el país. “No se observa el accionar del Gobierno y de los ayuntamientos administrados por el PRM tratando de buscar correctivos o acciones preventivas a las inundaciones en las ciudades y los daños en las carreteras y caminos”, declaró Olgo Fernández, secretario de Obras Públicas del PLD.
actualmente no se pueden considerar extraordinarias, porque se vienen rea-
lizando religiosamente desde el 2020, semana tras semana, mes tras mes y año tras año en las 31 provincias, el Distrito Nacional y todos sus municipios y distritos municipales en varias ocasiones, por lo que, no violaremos la resolución 38-23 de la Junta”. Peña se pronunció en estos términos tras la JCE prohibir a las instituciones del Estado, todo tipo de actividades sociales o comunitarias extraordinarias, hasta pasadas las elecciones congresuales y presidenciales del 19 de mayo próximo.b
País Posible lanza el programa “Yo voto y defiendo mi voto”
SANTO DOMINGO. El Partido País Posible (PPP) lanzó el programa “Yo voto y defiendo mi voto”, con el que motiva a los ciudadanos a ser observadores de escrutinio, para entrar a los colegios electorales y participar en el proceso de conteo de los votos. El presidente del PPP, Milton Morrison, informó que los observadores de escrutinios que representen a su organización, recibirán un carnet inteligente con una membresía, con el cual obtendrán descuentos y ofertas en más de 20 establecimientos comerciales del país, siendo la primera organización que marca este precedente en República Dominicana. b
Noticias OpiniónRevistaDeportes Jueves, 9 de mayo de 2024 DiarioLibre. 10 /
Vinicio Castillo Semán participó en El Cafecito Político
MATÍAS BONCOSKY
CAFECITO POLÍTICO
Tony Peña Guaba
FUENTE EXTERNA

Jueves, 9 de mayo de 2024 DiarioLibre. / 11
ENCUESTA MARK PENN/STAGWELL/NOTICIAS SIN
El debate presidencial no afectó decisión del voto
El ejercicio entre los candidatos no cambió el parecer del 89% de los votantes
Diario Libre
SANTO DOMINGO. Para los probables votantes que fueron entrevistados para la encuesta Mark Penn/Stagwell/Noticias SIN, la celebración del debate no les hizo cambiar su oponión para cuando vayan a las urnas el 19 de mayo.
Debate presidencial no afectó el voto
Aunque un tercio de los dominicanos no vio el reciente debate presidencial, entre aquellos que lo sintonizaron, Luis Abinader fue el candidato que un 36% considera que tuvo la mejor participación. Leonel Fernández sacó un 23%. Un 30% de los encuestados dice que no vio el debate.
Quién salió mejor parado
El 89% de los dominicanos que vio el pasado debate presidencial, indica que este no hizo que su intención de voto cambiara de cara a las elecciones presidenciales de mayo. Un 36% de los entrevistados consideró que Luis Abinader quedó mejor parado en el debate, contra un 23% que mencionó a Leonel Fernández y un 9% que citó a Abel Martínez. Un 30% aseguró que no vio el debate.
Mientras tanto, un 60% de los perremeístas y un 64% de los simpatizantes de la Fuerza del Pueblo indicaron que Luis Abinader y Leonel Fernández quedaron mejor parados. Sin embargo, entre los pe-
ledeístas apenas un 33% citó a Abel Martínez y un 29% a Leonel Fernández. Un alto 38% de los independientes no vio el debate y en cuanto a quién quedó mejor parado se dividió en un 26% respectivamente entre Luis Abinader y Leonel Fernández.
El PRM sacaría un 56% contra un 21% de Fuerza del Pueblo
Si las elecciones hubiesen sido a finales del pasado mes de abril del 2024, el candidato presidencial del PRM hubiese liderado con el 56%, 10% más que en la última medición.
En el 2023, la Fuerza del Pueblo hubiese sacado un 25% de los votos.
Cuando se buscó la intención del voto por el candidato de un partido, un 56% indicó que votaría por el del PRM lo que es un 10% más que hace un
¿Quién cree usted que salió mejor parado durante el debate reciente por televisión entre Luis Abinader, Leonel Fernández y


El haber visto por televisión el debate entre los tres candidatos, ¿hizo que usted cambiara en su intención de voto? Base =842



Si las elecciones presidenciales fueran hoy, ¿por el candidato presidencial de cuál partido votaría usted? En porcentaje
año. Un 21% indicó que votaría por la Fuerza del Pueblo contra un 25% de hace un año.
Asimismo, un 12% votaría por el PLD contra un 16% de hace un año, mientras un 95% y 94% de los simpatizantes del PRM y Fuerza del Pueblo votarían por su propio partido, en contraste con tan solo un 86% de los peledeístas que votaría por su partido.
Un 43% de los independientes votaría por el PRM, un 23% por la Fuerza del Pueblo y un 11% por el PLD y un alto 13% está indeciso.
En cuanto a los partidos
pequeños tan solo un 3% votaría por ellos.
Un alto nivel de independientes.
Aunque los que dicen que simpatizan por un partido político han ido aumentando durante los últimos tres años llegando ahora a un 61%, todavía un 39% se considera independiente, proporción alta. Cuando comenzamos a hacer encuestas políticas en 1982 los independientes apenas eran un 7%. Más aun, un 52% de los jóvenes de entre 18 y 24 años de edad hoy se considera independiente. b
Declaración de metodología
4
Mark Penn / Stagwell (certificado No. 2019-09046 de la JCE) efectuó esta encuesta de cara a cara ante 1,206 encuestados quienes han indicado que de seguro probablemente votarán en mayo del 2024. El trabajo de campo fue realizado entre el 25 y el 28 de abril, es decir después del debate electoral. El margen de error es de más o menos 2.8%. Los datos fueron ponderados para ser representativos de la población dominicana, y el público con mayor probabilidad de votar en mayo de 2024 se identifica entre esta población. Los resultados están analizados por género, edad, y educación. En este reporte, preguntas claves fueron comparadas con mediciones anteriores realizadas en octubre del 2022 y mayo del 2023. Los datos fueron recopilados por un equipo de trabajo y alojados en una plataforma segura e independiente. Esta encuesta fue auspiciada por un grupo del sector privado dominicano. Mark Penn y sus empresas han estado realizando encuestas políticas en RD hace más de 40 años.
Noticias OpiniónRevistaDeportes Jueves, 9 de mayo de 2024 DiarioLibre. 12 /
Fuente:
MARK PENN/STAGWELL/NOTICIAS SIN
Abel Martínez?
ENCUESTA
Gráficos: Shanny Valdez / Diario Libre
Base total =1,206 36 % Luis Abinader 23 % Leonel Fernández 30 % No vi el debate 2 % NS/NC 9 % Abel Martínez 10 % 89 % 1 % Si No No sé 56 46 38 21 25 18 12 16 18 6 7 8 3 2 22 4 6 2024 2023 2022 n=1,206 n=1,197 n=1,197 El del PRM El de la FP El del PLD Por el de otro partido
Suspenden alcaldes y regidores electos como proveedores
La DGCP ofreció los nombres de 211 funcionarios electos en los comicios de febrero
SD. La Dirección General de Contrataciones Públicas (DGCP) informó ayer la suspensión de oficio de los Registros de Proveedores del Estado (RPE) de 211 alcaldes, vicealcaldes, regidores, directores y subdirectores de juntas distritales que resultaron electos para el periodo 2024-2028.
De acuerdo con la resolución No. DGCP-01-2024, las autoridades municipales se encuentran dentro del régimen de inhabilidades dispuesto en el artículo 14 de la Ley 340-06 de Contrataciones Públicas.
La normativa establece que estos funcionarios no podrán ser oferentes ni contratar con el Estado para suplir bienes, obras y servicios a las instituciones gubernamentales hasta seis meses después de

su salida del cargo.
El director general de Contrataciones Públicas, Carlos Pimentel, aclaró que esta medida no constituye una sanción sino, más bien, que busca prevenir posibles conflictos de interés en aras de contribuir con la transparencia en las adquisiciones gubernamentales. Pimentel exhortó a las nuevas autoridades municipales a gestionar sus procesos de compras a través del Sistema Electrónico de
Contrataciones Públicas (Portal Transaccional), que es la plataforma de uso obligatorio para la gestión de los procesos de compras y contrataciones de los organismos sujetos al ámbito de aplicación de la Ley 340-06, para garantizar el cumplimiento de los principios de participación, transparencia y publicidad. Adelantó que tras las elecciones del 19 de mayo, procederán con las suspensiones de registros de quienes resulten elegidos. b


Noticias OpiniónRevistaDeportes Jueves, 9 de mayo de 2024 DiarioLibre. / 13
Carlos Pimentel, director de la DGCP.
ARCHIVO
Minerd y ADP continuarán el diálogo tras las elecciones
Educación propuso ayer aumento adicional de un 2%, en junio, en adición al 8% dispuesto en mayo
C.
González / P. Sánchez
SANTO DOMINGO. El Ministerio de Educación (Minerd) y la Asociación Dominicana de Profesores (ADP) retomaron ayer el diálogo respecto a las acciones que faltan por ejecutar del acuerdo del 2021. Tras dos horas reunidos, el Defensor del Pueblo, Pablo Ulloa, manifestó que buscan que continúen las conversaciones.
Los próximos encuentros serán pautados luego de las elecciones presidenciales y congresionales del 19 de mayo.
Indicó que en las demás reuniones se irán conciliando los once puntos pendientes, entre ellos, el incremento salarial, el tema los docentes pensionados, los hospitales y servicios de salud, las infraes-
tructuras de las escuelas, los incentivos a los coordinadores docentes, las evaluaciones docentes y la casa de los docentes, que son espacios que se crearán en distintos puntos del país para que los maestros puedan reunirse.
Además, abordarán la mejora de los programas de aprendizajes, que, según la ADP, tienen deficiencias metodológicas.
Paro de docencia
Respecto a la paralización de la docencia, Eduardo Hidalgo, presidente de la ADP, dijo que se reuniría con su comité ejecutivo en la tarde de ayer para decidir si continuarán los paros programados en la región Este y el Gran Santo Domingo.
Sin embargo, a la salida del encuentro interno no

ofrecieron declaraciones al respecto.
La carta de Hernández
En una carta enviada por Ángel Hernández, ministro de Educación, a Eduardo Hidalgo, titular de la ADP, este le comunica que, tras sugerencia de la Comisión Mediadora, “he consultado con el presidente Luis Abinader escalar un 2 % adicional al 8 % ya aplicado a la nómina de mayo”.
El nuevo aumento sería efectivo a partir del próximo junio. “La preocupación es ahora recuperar el tiempo perdido...”, señala la carta fechada el 8 de mayo, a la que tuvo acceso Diario Libre. Hernández también le pidió a la ADP designar a los miembros de la comisión para establecer el calendario de ejecución de las prioridades señaladas en la reunión que sostuvieron ayer


CMD y Adars tratan alza de cobertura
Los galenos y las aseguradoras se reunieron en las oficinas de Adars
Claudia Fernández
SD. El presidente del Colegio Médico Dominicano (CMD), Waldo Ariel Suero, informó que la institución que representa, las Sociedades Especializadas y la Asociación de Administradoras de Riesgos de Salud (Adars) sostuvieron un encuentro donde trataron la revisión de las tarifas de consultas ambulatorias y su sometimiento ante el Consejo Nacional de la Seguri-
dad Social (CNSS). Sin abundar en los detalles, Suero indicó, a través de un comunicado, que la reunión se desarrolló en un ambiente de armonía, donde además del presidente de Adars, José Manuel Vargas, también estuvieron presentes ejecutivos de las ARS Primera, Mapfre Salud, Futuro, Monumental y Yunén. Asimismo, conversaron sobre la asignación de códigos por parte de las Administradoras de Riesgos de Salud (ARS), pautándose un segundo encuentro junto a los directivos de la Asociación de Clínicas y Hospitales (Andeclip).
SP dice dengue está controlado; la OPS registra 7,931 casos
Atallah encabezó el lanzamiento de campaña “Familia antidengue”
Claudia Fernández

SD. Durante el acto de lanzamiento de la campaña “Familia antidengue en entornos saludables”, el ministro de Salud Pública, Víctor Atallah, aseguró este miércoles que “hasta el momento, los casos de dengue están en descenso y controlados”. Al ser consultado sobre las cifras de casos sospechosos, Atallah omitió el dato una vez más, pero, la Organización Panamericana de la Salud (OPS) indica que hasta la semana 18, el país registra 7,931 sospechas; 56 de gravedad y 781 confirmados por laboratorio. Atallah resaltó que “es extremadamente importante entender que, tenemos un periodo de lluvias fuertes y que el Ministerio, por vez primera, se ha anticipado mucho antes a esta campaña de dengue”. “Viene la parte que queremos evitar: el ascenso normal que pasa cuando empieza a subir la temperatura y el episodio de lluvias en mayo, por eso nos estamos adelantando”, dijo.
Noticias OpiniónRevistaDeportes Jueves, 9 de mayo de 2024 DiarioLibre. 14 /
FUENTE EXTERNA
Se pautó un próximo encuentro junto a Andeclip.
El ministro Víctor Atallah.
Pablo Ulloa inició la mediación entre la ADP y el Minerd.
FUENTE EXTERNA
Juicio
a red explotaba extranjeras aún no
inicia
SD. A seis meses de dictarse apertura a juicio de fondo en el caso de la red que explotaba sexualmente a venezolanas y colombianas, esa etapa del proceso todavía no empieza por los constantes reenvíos. Al grupo de acusados, un total de 23 personas físicas, un hotel de Gascue y otro de Bávaro, Punta Cana, se persigue penalmente después que se iniciara una investigación, denominada Operación Cattleya.
Ayer se intentó nuevamente empezar el juicio, que conoce el Tercer Tribunal Colegiado del Distrito Nacional, pero se aplazó por la ausencia del abogado del acusado
Robert Lee Eleuterio Paniagua Díaz y por la ausencia de una intérprete del creole, que envió una excusa.
El tribunal postergó la audiencia para el 15 de este mes de mayo.
Conocerán mañana solicitud de coerción a Francelys Furcal
Ayer, jueza aplazó su conocimiento a petición de abogado de la acusada
Marisol Aquino
SD. Será este viernes, que se le conocerá la audiencia de solicitud de medida de coerción contra Francelys Furcal, acusada de matar a su jefe, de nacionalidad china, en una ferretería del ensanche Luperón, en el Distrito Nacional.
La fiscalía del DN solicita prisión preventiva en su contra. La jueza, Fátima Veloz acogió la petición que hiciera Tomás Castro, abogado de Furcal, quien alegó que no tenía copia del expediente ni había sido notificado. Castro afirmó que al no disponer de la imputación presentada por el Ministerio Público, no tenía los elementos necesarios para rebatir las acusaciones contra Francelys.
 Francelys Furcal
Francelys Furcal
De acuerdo con calificación jurídica
El abogado de la familia de Jhei Leet o Chen Zongxin, la víctima, dijo ayer que están de acuerdo con la calificación de homicidio voluntario que hizo el Ministerio Público.
El togado José Chía sostuvo que la consideran “prudente” y que apoyan todos los tipos penales de los que el órgano acusador imputa a Furcal, quien infirió una herida mortal a Leet que le causó la muerte en abril del 2022.


Noticias OpiniónRevistaDeportes Jueves, 9 de mayo de 2024 DiarioLibre. / 15
Reportaje
En España hay entre 25,000 y 30,000 mujeres en situación de explotación sexual
Prostitución y trata de dominicanas en España, entre engaños y maltratos
Álvaro de Araoz
SD. En la actualidad, en España hay entre 25,000 y 30,000 mujeres en situación de explotación sexual. El 85 % son de origen extranjero, de las cuales hay entre 2,800 y 3,470 dominicanas, el 13.4 %. “Te piden 10,000 euros para casarte con un español, y así obtener la nacionalidad española, pero te obligan a trabajar en los clubes y pisos de trata” relata una de las víctimas sobre el horror de tener que prostituirse.
Aseguran que en España hay cerca de 800 prostíbulos, 2,500 pisos y 50 lugares de calle donde se lleva a cabo este negocio sexual. En sus informes muestran
cómo la media de edad de las personas en esta situación se sitúa en los 35 años
Las personas de nacionalidad dominicana no son la comunidad más numero-
In Género
La asociación In Género, la cual ha proporcionado estos datos está enfocada en atender a víctimas de trata y explotación sexual, además de personas en situación de prostitución. Teléfono emergencias 24 horas del día: +34 670 962 616
sa, pues de ese 85 % de extranjeros, un 29.1 % son colombianas y un 15.5 % paraguayas; el resto se reparten entre venezolanas (7.8 %), rumanas (7 %), brasileñas (6 %), ecuatorianas (3.3 %), peruanas (2.5 %) y cubanas (1.9 %). Tan solo el 4.5 % eran españolas.
¿Cómo llegan a está situación?
En un estudio publicado el 2022 conjuntamente por el Instituto Tecnológico de Santo Domingo (INTEC), el Instituto Nacional de Migración de la República Dominicana (INMRD) y la Unión Europa, titulado la Trata de Mujeres Dominicanas, se dice que muchas de las sobrevivientes de tra-


Las dominicanas son el 13.4% de las prostitutas en España.
ta venían de círculos de violencia intrafamiliar, violencia sexual en su niñez y adolescencia, y de violencia de género con sus parejas. Una de ellas, que quiere permanecer en el anonimato, relató que fue víctima del maltrato y eso le cambió la vida: “Mi hija se enfermó en un momento en el que creía que me moría, yo salí adelante por ella. Por mi hija tuve la fuerza de dejarlo todo y me fui a casa de mi madre, en una comunidad fronteriza con Haití” Sobre cómo llegó a Espa-
ña, ella afirma que se puso en contacto con un amigo de la familia, que estaba haciendo un “trapicheo con unos contratos con unos eslovenos que ofrecían casa, alimentación, un salario de 700 euros...Y pensé, trabajo dos años y por lo menos les compro una casa a mis hijos”. Una de las formas de llevar mujeres para la trata sexual es la promesa de la obtención de la nacionalidad española. Otra de las víctimas relataba en el informe que “se les pide 10,000 eu-
ros para casarlas con un español, y así obtienen la nacionalidad española, pero les obligan a trabajar en los clubes y pisos de trata”. De la encuesta de In Género, se estima que un 36.9 % se encontraba en situación administrativa irregular, un 53.7 % regular, el 2.7 % tenía visado turístico y el 6.7 % estaba tramitando su documentación.
El 63.2 % de las personas atendidas afirman que llegaron a España con un objetivo distinto al de la prostitución, mientras que el 36.8 % restante sí sabía que lo haría.
Los casos más recurrentes son los de las mujeres en situación vulnerable en países de América Latina que son captadas para que viajen a España con engaños de un trabajo y luego son explotadas sexualmente. Más del 95 % de las personas en contextos de prostitución tienen cargas familiares y alrededor de un tercio de ellas ha recurrido a los servicios sociales, mientras que un 47.8 % ni siquiera los conoce.
Reportaje completo en diariolibre.com

Noticias OpiniónRevistaDeportes Jueves, 9 de mayo de 2024 DiarioLibre. 16 /
ARCHIVO
RD expuesta a riesgos naturales sin idónea protección financiera
Diagnóstico del PNUD, con apoyo del gobierno Alemán, expone riesgos del país y limitado alcance de respuesta
SANTO DOMINGO. Aunque la República Dominicana ya tiene medidas como la redistribución del presupuesto estatal, el acceso a créditos y la asistencia humanitaria para hacer frente a emergencias, para acontecimientos graves, estos mecanismos resultan insuficientes, lo que supone una amenaza para las finanzas públicas y el crecimiento, aumentando, de ese modo, los riesgos del país.
Así lo revela un informe resumen del diagnóstico “Seguros inclusivos y financiamiento de riesgos en la República Dominicana: panorama actual y perspectivas futuras”, presentado por el Programa de las Naciones Unidas para el Desarrollo (PNUD), a través de la Iniciativa de Financiamiento de Riesgos y Seguros (IRFF), apoyada por el gobierno de Alemania.
El diagnóstico fue divulgado ayer en un evento que contó con el apoyo de la Cámara Dominicana de Aseguradores y Reaseguradores (Cadoar), empresas
asociadas a esa organización y la Superintendencia de Seguros. Este señala que, a pesar de los instrumentos existentes que incluyen líneas de crédito, préstamos contingentes y una línea presupuestaria específica para emergencias públicas y acontecimientos de gravedad, “los actuales mecanismos de financiamiento
Baja cobertura seguro agrícola
Solo aproximadamente el 8 % de los productores agrícolas están cubiertos por un seguro, indica el análisis. Destaca que Agrodosa es la única aseguradora que ofrece seguros agrícolas y ganaderos en el país. El gobierno subvenciona el 50 % de la prima a los pequeños y medianos productores, pero el presupuesto es insuficiente.

son insuficientes, lo que supone una amenaza para las finanzas públicas y el crecimiento, aumentando los riesgos en el país”.
Indica que la falta de criterio oficial para clasificar los microseguros, dificulta la medición de su penetración, y precisa que varias aseguradoras ofrecen productos para el mercado de bajos ingresos, pero solo una tiene como principal mercado objetivo ese segmento. El análisis identifica la informalidad y la baja bancarización, como parte de los desafíos para seguir desa-
rrollando el mercado para los más vulnerables.
Las amenazas
Algunos de los datos del país que contiene este diagnóstico resaltan que las inundaciones han afectado a más personas en la República Dominicana que cualquier otro peligro natural, perjudicando a 4.36 millones de personas entre 1980 y 2022 como resultado de 29 grandes desastres por inundaciones.
Solo en el 2016, tras cuatro semanas de fuertes lluvias entre octubre y noviembre, las inundaciones golpea-
ron a 30,100 personas y causaron daños por valor de 4,390 millones de pesos en bienes y servicios públicos y privados.
Expuesta
De hecho, la situación geográfica de la República Dominicana la expone a una amplia gama de riesgos naturales. Ocupa el puesto 40 de 193 países en cuanto a vulnerabilidad a los riesgos de catástrofe.
Entre 1980 y 2022, indica el diagnóstico, 74 grandes desastres de origen natural afectaron a 7.22 millones de personas, y el 25.1 % de la
población es muy vulnerable a los fenómenos extremos, que afectan especialmente a los hogares rurales.
Recomendaciones
Según el diagnóstico, elaborado por el Centro de Microseguros de Milliman, para apoyar el desarrollo de seguros inclusivos, las intervenciones deben incluir el desarrollo de un entorno legislativo y reglamentario propicio para los microseguros, la mejora de las ofertas de productos y distribución para las personas de bajos ingresos, la educación de los consumidores y la capacitación del mercado, y el desarrollo de una estrategia para los seguros agrícolas que genere eficiencia y competencia.
25.1 %
Porcentaje de la población dominicana muy vulnerable a los fenómenos extremos.
También, para mejorar el financiamiento del riesgo de desastres, sería útil intervenciones en el apoyo a la creación de mecanismos y sistemas de coordinación de datos, aumentar la comprensión del riesgo fiscal ante desastres naturales, desarrollar una estrategia de financiamiento de riesgos de desastres, dar asistencia técnica para desarrollar la capacidad y el uso de los instrumentos de financiación de riesgos.
Las mipymes de la construcción reclaman más recursos
Sugieren el fideicomiso para evitar fraudes en el sector
Joaquín Caraballo
SANTO DOMINGO. El presidente de la Confederación Dominicana de Micro, Pequeñas y Medianas Empresas de la Construcción (Copymecon), Eliseo Cristopher, llamó ayer a las autoridades monetarias a crear los mecanismos para
cuando se liberen recursos del encaje legal estos lleguen a las mipymes del sector construcción, lo que se convertiría en una garantía para el crecimiento económico del país. “Decimos que Banco Central, Superintendencia de Bancos y Junta Monetaria deben buscar las formas de liberar recursos y que sí lleguen a las mipymes, estableciendo normativas y mecanismos oportunos para que esos recursos lleguen a las
mipymes de la construcción”, indicó Cristopher. Señaló que las grandes empresas pueden adquirir dinero prestado para financiar sus proyectos a un 8 y 9 %, y las mipymes lo pagan a un 15, 16, 17 y 18 %. “Solamente en el caso de los intereses”.
Fraudes inmobiliarios Cristopher habló sobre el tema en el marco del 1er Foro de la Construcción Copymecon 2024, donde llamó a los adquirentes a

comprar bajo el fideicomiso. “Ustedes están escuchando que por ahí están hablando de estafas inmobiliarias. Nosotros aprovechamos el escenario (para recomendar) hacer y adquirir viviendas que estén bajo la figura del fideicomiso, donde están todas las reglas claras”, agregó. Dijo que bajo ese panorama salen favorecidos el constructor y los inversionistas y, sobre todo, se garantizan los recursos de los adquirentes.
Precio del cemento El presidente de Copymecon también se refirió al aumento de precio de la funda de cemento, señalando que esto impacta de manera directa en el valor de las viviendas. “Se ha mantenido subiendo y es una constante, lo que nos alerta. Nosotros el año pasado teníamos cerca de 100 pesos menos y el día de hoy se está consiguiendo a 550, 525, 490 pesos la funda”, apuntó.
Noticias OpiniónRevistaDeportes Jueves, 9 de mayo de 2024 DiarioLibre. / 17 ECONOMÍA Petróleo Barril en WTI. Datos en US$ Dólar Datos en RD$ VentaCompra Euro Datos en RD$ Compra 79.13 78.11 78.79 78.51 78.99 J2V3L6M7 M8 58.2358.24 58.33 58.43 58.46 57.8457.8657.83 57.97 57.99 J2V3L6M7 M8 61.88 62.17 62.32 62.41 62.3 J2V3L6M7 M8 DiarioLibre. 17 / Jueves, 9 de mayo de 2024
Eliseo Cristopher
Inka Mattila, representante del PNUD, se dirige al público en la presentación del análisis.
ABA: modificación al reglamento de subagentes bancarios facilita acceso
La banca múltiple saludó ayer la medida de la Junta Monetaria
SD. La Asociación de Bancos Múltiples de la República Dominicana (ABA) saludó ayer las modificaciones realizadas al Reglamento de Subagente Bancario por parte de la Junta Monetaria, al considerar que se introducen disposiciones oportunas que facilitan y amplían el acceso a
los servicios financieros en el territorio nacional. Consideró como relevante la extensión del alcance de esta figura mediante la habilitación de las corporaciones de crédito para operar subagentes bancarios y la incorporación de nuevos tipos de establecimientos del sector público y privado que tienen la posibilidad de ofrecer el servicio. Calificó de positivo que, en lo adelante, se abra una oportunidad de negocios y de ofrecer servicios para las Cliente ejecuta un proceso.

entidades que fueron incluidas en este catálogo, entre las que figuran: oficinas de correos; centros de salud, educativos, de telecomunicaciones, de expendio de alimentos y de transporte; consultoras jurídicas; salones de belleza; tiendas y comercios minoristas. “La habilitación de esas sociedades como subagentes permitirá a un mayor número de usuarios tener acceso a productos y servicios bancarios”, aseguró la ABA.b


Destacan avances del país en uso de la IA en empresas
El Banco Popular celebró su décimo Foro Impulsa, con 1,500 empresarios
María del Carmen Guillén
SANTO DOMINGO. Para este 2024, el 73 % de las empresas del Caribe y Latinoamérica tiene previsto invertir en inteligencia artificial (IA), posicionando a República Dominicana como uno de los líderes de la región en la intención de integrar la IA en las empresas, planteó ayer el director de Pymes y Empresas Nativo-Digitales de Microsoft, Roberto Icasuriaga. El experto fue uno de los oradores invitados por el Banco Popular para el desarrollo de su encuentro de innovación Foro Impulsa Popular, en el que Icasuriaga abordó el tema “El poder transformador de la Inteligencia Artificial en las empresas de República Dominicana”. Al responder algunas preguntas de Diario Libre, sobre el uso de la IA en el país, dijo: “Vemos un impulso muy grande al tema de la inteligencia artificial en República Dominicana. Este evento con más de 1,200 personas demuestra una de las cifras que mostraba hoy (ayer) en la mañana, de que para este año el 73 % de las empresas planean invertir en inteligencia artificial, en particular en República Dominicana”.
Fortalece el empleo
Lejos del desplazamiento de empleos, lo que va a permitir la inteligencia artificial es amplificar las capacidades de
una persona. “Reemplazar a una persona es muy difícil, porque la inteligencia artificial no tiene sentimientos, por decirlo de alguna manera, no tiene sensibilidad”, explicó el experto. Para Icasuriaga, lo que tiene la IA es una capacidad muy grande de tomar muchos datos agregados y presentarlos de una forma rápida, de analizarlos y combinarlos para responder a tareas específicas, como formular cálculos, transcribir audios y, entre otras cosas, evaluar similitudes en exámenes médicos.
Con la IA, se están creando trabajos nuevos de cómo hablarle a la inteligencia artificial y otros trabajos, quizás más rutinarios, que en el futuro se podrán modernizar, precisó. Sobre el costo para que las empresas adopten la IA, dijo que se deberá aplicar tarde o temprano.b
Mujeres en las Pymes Popular
La entidad financiera informó que tiene 71,500 clientes pymes que forman parte de su plataforma Impulsa, donde un 24 % están dedicadas al sector servicios, 26 % a la categoría de comercio, 14 % al sector manufacturero y 36 % al inmobiliario, distribuyéndose el resto del porcentaje entre otros sectores de la economía. De este grupo de clientes pymes un 24 % son empresas lideradas por mujeres.
Noticias OpiniónRevistaDeportes Jueves, 9 de mayo de 2024 DiarioLibre. 18 /
FUENTE EXTERNA
Expertos que debatieron sobre la IA en Foro Impulsa.
4

QUÉ CURIOSO
PLANETA PARA PENSAR
Más del 30 % de la electricidad producida en 2023 en el mundo fue de origen renovable, según el Centro de Investigación Energética Ember. Estudios indican que se mantendrá la tendencia al aumento.
Lluvias inundan zonas urbanas y agrícolas de RD; afectan decenas de acueductos y puentes
El COE reportó ayer que 34 acueductos estaban inhabilitados
También varias comunidades quedaron incomunicadas
Melbin Gómez
SD. Los fuertes aguaceros que se registran sobre el territorio nacional desde hace varios días, debido a la incidencia de una vaguada, han provocado inundaciones en diferentes localidades y a la vez han incomunicado algunas comunidades de provincias del interior del país. De acuerdo al reporte de la situación del país emitido este miércoles por el Centro de Operaciones de Emergencias (COE), en el Distrito Nacional debido a las fuertes lluvias se produjeron inundaciones urbanas en la avenida Rincón, del sector Los Guandules, y en el sector Sabana Perdida, en Santo Domingo, se desbordó la Cañada el Manguito provocando que unas 60 viviendas quedaran anegadas.
Las lluvias de la tarde de este miércoles sobre el Distrito Nacional también alargaron los habituales taponamientos que caracterizan las vías del área metropolitana en horas vespertinas.
Las incomunicadas
El reporte del COE indica que debido a la saturación de los suelos se produjo un deslizamiento de tierra quedando incomunicadas parcialmente la comunidad La Tinaja con Sobacón, en Elías Piña.
En Monte Plata, a causa del desbordamiento del río Ozama quedaron incomunicadas las comunidades: Serrallés, La Cuaba, la Gina y Centro de Penso. Además, por el desbordamiento del río El Mogote quedó incomunicada la comunidad Peralvillo.
Viviendas en La Vega Debido a las fuertes lluvias se produjeron inundaciones urbanas en La Vega en los sectores: Las Carolinas,

El Vedado, San Miguel, El Nápoles, La Sánchez, Villa Francisca, Los Robles, Parque Lineal en la calle Juan Rodríguez, Barrio Lindo, Barrio Inco, Las Carmelitas, El Tanque, Profesor Juan Bosch, además en El Hatico resultaron unas 699 viviendas anegadas. También por el desbordamiento de los ríos Camú, Pontón y Bauticito fueron afectadas las comunidades: Distrito Municipal de Cutupú, Distrito Municipal de Ranchito, Distrito Municipal Juan Rodríguez, Las Cabuyas, Bacui, Rancho Viejo, Pontón, El Pinito, Carrera de Palma, Guiguí, Bayacanes, Las Maras, El Higüero, Carrera de Palma, resultando unas 737 viviendas anegadas en dichas zonas. En la provincia Duarte, se produjeron inundaciones específicamente en la comuni-
La imagen muestra la inundación ayer en la calle Dr. Defilló, de Los Prados.
dad Los Rieles, en Villa Riva. Las provincias Duarte (especial el Bajo Yuna), La Vega, Puerto Plata, Santiago Rodríguez y Montecristi se encuentran en alerta roja. En total son 27 las provincias en alerta, cinco en roja, 18 en amarilla y 4 en verde.
Desborde Río Soco
La Defensa Civil informó que por el desbordamiento del Río Soco quedaron incomunicadas las comunidades, Concho Primo, Diego, Loma Alduey, Campiña, Platanito, bejucal, Cabeza de Toro y Guanabano.
Acueductos
Según el informe, en varias provincias del país unos 34


“Hemos creado una vacuna que proporciona protección contra una amplia gama de coronavirus diferentes”
Rory Hills
Investigador Universidad de Cambridge
Diario de nutrición
Dra. Erika Pérez Lara
¿Es tu microbiota intestinal la culpable de que no puedas perder peso?
En los últimos años, la comunidad científica ha estado cada vez más interesada en el papel que juega nuestra microbiota intestinal en diversos aspectos de nuestra salud. Uno de los temas más sorprendentes y estudiados es la influencia de estos microorganismos en el metabolismo y, consecuentemente, en el control del peso corporal. La pregunta que surge es: ¿puede la composición de nuestra microbiota intestinal ser la razón por la cual algunas personas encuentran difícil perder peso o tienden a ganarlo rápidamente?
La microbiota intestinal está compuesta por billones de bacterias que residen en nuestro tracto digestivo. Estos microorganismos no son meros espectadores; participan activamente en procesos metabólicos esenciales, incluyendo la digestión de alimentos, la producción de vitaminas y la regulación del sistema inmune. Investigaciones recientes sugieren que la diversidad y el equilibrio de estas bacterias pueden influir significativamente en la forma en que nuestro cuerpo procesa los alimentos y almacena grasa.
acueductos están fuera de servicio, debido a las fuertes lluvias, lo que generó alta turbidez afectando unos 381,382 usuarios.
COE mantiene alerta
Ante el incremento de las lluvias, ayer miércoles, el COE enfatizó su llamado a la ciudadanía de abstenerse de cruzar, ríos, arroyos y cañadas que presenten altos volúmenes de agua en las provincias bajo alerta.
Trabajos Alcaldía DN
La alcaldesa del Distrito, Carolina Mejía, dispuso intensificar los trabajos de brigadas y camiones de succión como medida para mitigar los efectos ante las lluvias generadas debido a una vaguada, informó ayer la institución. Brigadas del DN asumieron los trabajos en coordinación con el Cuerpo de Bomberos. Las labores incluyeron la poda de árboles y limpieza de imbornales y alcantarillas. Priorizaron las intervenciones en tramos de la avenida 27 de Febrero, Los Guandules, San Carlos, así como en la intersección de la avenida John. F. Kennedy con Dr. Defilló, en la Ortega y Gasset, la Ciudad Moderna y las aceras del Club Los Prados, entre otros, con camiones succionadores.
Un estudio clave publicado en la revista ‘Nature’ en 2006 por Turnbaugh y colegas demostró que los ratones que recibieron trasplantes de microbiota de donantes obesos mostraron un aumento significativo en la masa corporal en comparación con aquellos que recibieron microbiota de donantes delgados, incluso cuando consumían una dieta idéntica. Este hallazgo sugiere que la microbiota intestinal puede afectar la eficiencia energética de los alimentos y la predisposición al almacenamiento de grasa.
La implicación para los humanos es igualmente fascinante. Investigaciones han mostrado que las personas obesas tienden a tener una composición diferente de microbiota intestinal en comparación con individuos delgados. Por ejemplo, un aumento en la proporción de Firmicutes a Bacteroidetes (bacterias que forman parte de la microbiota intestinal normal) ha sido asociado con la obesidad. Estos estudios indican que manipular la microbiota podría ser una estrategia viable para modificar cómo nuestro cuerpo maneja las calorías.
Sin embargo, la relación entre la microbiota y el peso corporal es compleja y está influenciada por múltiples factores, incluyendo la genética, la dieta y el estilo de vida. Por lo tanto, aunque la evidencia es prometedora, no es definitiva. No podemos decir con certeza que la microbiota es “culpable” del aumento de peso en todos los casos, pero sí es un factor contribuyente significativo en muchos. Además de los cambios en la dieta y el ejercicio, algunos estudios sugieren que los probióticos y los prebióticos pueden ser útiles en la modificación de la microbiota para favorecer un perfil más beneficioso para el control del peso. ¿Cómo mejorar la microbiota? Desde lo más simple, incluir frutas enteras (no jugos) y verduras diariamente, evitar los alimentos procesados (cereales, dulces, embutidos) y consumir suficientes proteínas.
Para comunicarse con la Dra. Erika Pérez Lara, nutrióloga clínica, escriba a erikapereznutricion@gmail.com Instagram: @dra.erikaperezl
Noticias OpiniónRevistaDeportes Jueves, 9 de mayo de 2024 DiarioLibre. / 19
19 / Jueves, 9 de mayo de 2024 DiarioLibre.
KEVIN RIVAS
Personal de la Alcaldía del DN trabaja con camiones succionadores en diferentes zonas de la capital.
FUENTE EXTERNA
OPINIÓN
LA PREGUNTA DE AYER
¿Cree usted que habrá una solución para las huelgas de los maestros sin más paros de clases?
Vea la pregunta de hoy en www.diariolibre.com SI 38.23% NO 61.76%
EDITORIAL
Correcto el llamamiento
Dejamos de ser aquella comarca sometida a viejos patrones. Cada día nos alejamos de lo que fuimos. El cambio de los tiempos nos ha cambiado socialmente. De aquella comunidad acatada, rural y analfabeta no quedan ni nostalgias. La ciudad se mudó al campo con sus bancas, motoconchos, recargas, moteles y delíveris. Las campesinas ya no huelen a jabón de cuaba; ahora salen en Instagram y bailan dembow. Para bien o para mal, somos otros. Tratamos de convivir en la diversidad y nos cuesta acostumbrarnos. Ya la tradición o la cultura no nos igualan. Entramos así a una nueva convivencia agrietada por los choques de generaciones. La transición será difícil. Lo primero es derrotar el concepto de que la razón tiene dueños y luego entender que la de cada uno no es la de todos. Asumir esas premisas es un duelo para una sociedad de trazos autoritarios. La diversidad nos da vértigo. Es difícil aceptar que haya otros relatos de la realidad distintos a los que nos enseñaron. Antes, el abordaje era muy básico; se reconocían los valores públicos y privados en una relación vertical de gobernantes, elites y gobernados. Esos mundos estancos hoy están dominados por tendencias cruzadas de distintos intereses. El mapa social se fragmenta en grupos cada vez más menudos y diversos que demandan atenciones, derechos y espacios. Las llamadas minorías se centuplican y la verdad se quiebra en trozos. Los centros de autoridad, controlados por las mismas mentalidades, perdieron vigencia. No solo somos más, sino distintos, lo que hace complejas las decisiones colectivas. La construcción de consensos es, en ese contexto, una carrera empinada.
GRUPO DIARIO LIBRE
Ave. Buenaventura Freites #18, sexto piso, Jardines del Norte, Santo Domingo, República Dominicana. T: 809 476 7200 F: 809 616 1520 Apartado 20313. Santiago: 809 276 4278
Miembro de la Sociedad
Dominicana de Diarios
Miembro de la Sociedad
Interamericana de Prensa
Tirada de esta edición: 156,980 ejemplares
El llamamiento del presidente de la Junta Central Electoral (JCE), Román Jáquez Liranzo, dirigido a los partidos políticos, para que actúen con prudencia en las próximas elecciones, es correcto y debe ser apoyado. Existe una preocupación en la JCE y en diversos sectores de la sociedad, sobre la posibilidad de que se cree un clima de inestabilidad política tras las
Presidente ANÍBAL DE JESÚS DE CASTRO RODRÍGUEZ
Vicepresidente HAYDÉE KURET DE RAINIERI Secretario
GÓMEZ
elecciones del 19 de mayo. Los tiempos en que se usaban malas prácticas electorales y se generaban conflictos políticos para justificar victorias o derrotas no tienen espacio en la República Dominicana. Hemos logrado una estabilidad política que es envidiable, cuando se nos compara con otros países de la región, y no debemos renunciar a ella.
En directo
Condenados a entendernos
El llamamiento a todos los actores políticos es a mantener la paz social por encima de cualquier interés de corte político partidista.
El concepto de que en política todo se vale no debe ser aplicado a costa del bienestar de la sociedad. Aprendamos del pasado y apostemos por unas elecciones pacíficas, repletas de civismo y de democracia.
José Luis Taveras
Ya los grupos no solo nacen de las típicas disyunciones (como las basadas en el color, el grado social, el sexo o la religión), sino de ideologías emergentes vinculadas a otros valores: ciudadanía, identidad, género y generaciones. En tanto más abiertas sean las sociedades a la cultura global, más heterogéneas y conflictivas serán sus relaciones y perspectivas. Ahora nos cuesta educarnos en nuestras diferencias, que son muchas y profundas. Ya sentimos las tensiones de los desacuerdos. Pero debemos encontrar puntos que nos afecten indistintamente, y hay muchos en una sociedad de desatenciones acumuladas. Es un buen punto para comenzar... La tendencia de las sociedades ante la diversidad es recogerse en sus razones y empuñar la intolerancia como escudo defensivo. La historia confirma esa verdad, que ha tenido en el tiempo distintos nombres y pretextos: cristianismo, herejía, brujería, protestantismo, negrismo, comunismo, judaísmo, populismo y otros “ismos” perseguidos o aniquilados de distintas maneras; la misma marca en el negro relato de la intolerancia. Las sociedades reaccionan inmunológicamente con dos potentes antivirus: los estereotipos y la descalificación. Los primeros son

percepciones o creencias prejuiciosas sin base comprobada sobre gente o ideas. La segunda es la forma de restar valor o mérito a una persona a través de los estereotipos. La descalificación es la manera más rápida de sacar a las ideas del debate. Cuando una sociedad no tiene recursos de discusión, apela a los prejuicios para decapitar razones. Entonces lo que debiera ser un cotejo provechoso de visiones se vuelve un duelo de baratas anulaciones. De esta manera se hace escabroso apartar la ofensa de la opinión; lo subjetivo de lo razonable. La libre expresión en un medio tan atrincherado se enrarece. Y es que es incómodo encasillar a quien tiene la libertad como vocación o decisión de vida. La creencia corriente es aceptar el discurso de la mayoría. Pensar con criterios propios desafía la predecible imaginación de los que viven de las censuras; los confunde, los inquieta. Es como dar con una pieza con-
trahecha en un rompecabezas. Nací y crecí en una comarca de granjeros. Mis tíos fueron pioneros de la avicultura en el país. Una de las faenas más pesarosas era la vacunación de los pollitos bebés. El proceso era inhumano; suponía tomar manualmente diez mil pollitos y someterlos a tres operaciones seguidas: quemar sus piquitos en una barra incandescente; echarles, con precisión quirúrgica, una vacuna antiviruela en los ojitos; y, finalmente, inyectarles un antibiótico debajo de una de las alitas. La vacunación tomaba tres días con descansos muy constreñidos. La fatiga era tal que en ocasiones uno percibía el entorno como a través de un filtro amarillento. La ilusión visual duraba días. Para quebrar el tedio de la faena, mis primos tomaban algunos de los pollitos “desechables” (enfermizos, accidentados o no viables) y los tintaban de betún con un cepillo dental. Cuando ya estaban
El mapa social se fragmenta en grupos cada vez más menudos y diversos que demandan atenciones, derechos y espacios. Las llamadas minorías se centuplican y la verdad se quiebra en trozos. Los centros de autoridad, controlados por las mismas mentalidades, perdieron vigencia. No solo somos más, sino distintos, lo que hace complejas las decisiones colectivas.
totalmente marrones o negros, los soltaban en la granja. La reacción de los demás era picarlos hasta el linchamiento. Esa sádica travesura dejó en mi conciencia una perdurable lección de vida: ¡el precio de ser diferente! La sociedad de hoy me recuerda esa granja. La gente nos quiere “normal” hasta el punto de imponer lo que debemos ser o hacer dentro de las líneas, marcos y expresiones convencionales. Para ser alguien hay que abanderarse o dejarse etiquetar, so pena de diluirse en el ostracismo. Cualquier resistencia es sospechosa, ya que una sociedad acostumbrada al blanco y negro pierde la vista con el color. Por eso el juicio público es severamente dicotómico: estás de un lado o del otro. El problema asoma cuando no se está en ninguno, entonces se sufre el ataque de los dos lados: los negros te ven como un blanco y los blancos como un maldito negro. Lo más cómodo para algunos es jugar al péndulo según soplen las conveniencias. Las ideas son raptadas por los prejuicios y el debate se hace insustancial. Escuchar radio, ver televisión o entrar a las redes es sofocante. El discurso más aparatoso es el del insulto, arma que hoy se tiene como derecho de última generación. Hay una violencia verbal que nos divide. He leído diatribas hasta por el color de una bandera. Defender una posición con argumentos no significa que estemos transando con “el enemigo”. Es la manera racional de cimentar entendimientos humanos. Creo que nos llegó el momento de callar para escuchar: quizás nos demos cuenta de que eso era lo único que nos separaba. El estorbo puede ser nuestra propia voz. A veces, cuando callamos hablamos más alto.
DiarioLibre. 20 / Jueves,
de mayo de 2024
9
Subdirector Benjamín Morales Meléndez Jefe de Redacción: Dionisio Soldevila
Subjefes de Redacción: Niza Campos, Yvonny Alcántara
Jefe Audiovisual: Nelson Pulido
Jefa de Edición: Alicia Estévez
Editores: Beatriz Bienzobas, Mariela Mejía, Elina María Cruz, Karen Veras
Editora de Diseño: Ximena Lecona
ENRIQUE EDUARDO DE MARCHENA KALUCHE
LIONEL MARION LANDAIS PENZO Vocal MARCO ENRIQUE CABRAL FRANCO Comercial LAURA TIRADO Producción ELIUS
Tesorero
SAMIL MATEO
● 5:30 pm. Kentucky presenta su nuevo Chizza Sandwich. Lugar. Roberto Pastoriza, esq. Winston Churchill.
● 6:30 pm. La Escuela de Danza Leslie Ricardo presenta “Olé tú, Quisqueya”. Lugar: Sala Manuel Rueda, Teatro de Bellas Artes.

CALIENTE
Con motivo de la Semana del Libro de la Pontificia Universidad Católica Madre y Maestra, el poeta Mateo Morrison ofrecerá la conferencia “Puntos luminosos de la poesía dominicana” este miércoles 8 de mayo a partir de las 10 de la mañana. La Semana del Libro de la PUCMM está dedicada al Ateneo
Chiquito Team Band estrena
“A nuestro estilo”, un álbum romántico
con el sello de su sonido
b Los líderes de la agrupación, Enmanuel Frías y Rafael Berroa, trabajaron este disco durante un año y medio
Daniela Pujols
SANTO DOMINGO. “Los creadores del sonido”, Chiquito Team Band, presentaron su nueva apuesta discográfica “A nuestro estilo”, un álbum de salsa completamente romántico de 13 canciones.
En un encuentro con la prensa, los salseros dieron detalles del disco y presentaron el frente de orquesta conformado por Lemar, Arthur, Dayron y Enrique, cuatro talentosas voces que le darán un toque distinto a cada canción.
Durante un año y medio estuvieron trabajando este disco que fue resultado de una exitosa gira por Europa, donde recorrieron diversas ciudades de Alemania, España, Suiza e Italia. Se hizo en varias etapas: “Primero surgió el prototipo con una canción para ver cómo era la aceptación con ese tipo de salsa que íbamos a crear; se trató de ‘Si quieres’ y ya saben los resultados. Luego llegó ‘Perdóname’”, cuenta el director
Enmanuel Frías, conocido como Manuel Piano.
El cover “Si quieres” suma 38 millones de reproducciones y “Perdóname” acumula 16 millones en el canal de YouTube.
Esta última composición se ha popularizado con los
Amantes de la Luz, y la conferencia del Premio Nacional de Literatura 2010 será dictada en la Sala de Exposiciones de la Biblioteca Central, CSTI de esa institución. Asimismo, el escritor Mateo Morrison ha recibido una invitación para participar en el XXV Festival Mundial de Poesía en Caracas.
“Cuando entra un cantante o un músico le decimos ‘esto es una familia, una escuela, donde desarrollarse’. La música se trata de armonía, cuando no hay armonía en un grupo, no funciona”
Rafael Berroa ChiquitoTeam Band x
versos “Ni una sola palabra más, no más besos al alba, ni una sola caricia habrá, esto se acaba aquí, no hay manera ni forma de decir que sí”.
Surround o sonido envolvente
La prueba con las referidas canciones de salsa romántica salió exitosa y lo siguiente de Chiquito Team Band fue trabajar el álbum con la mayor calidad posible y en su propio estudio, del que Frías revela un detalle bastante interesante y diferente, poco visto en la salsa dominicana.
“A nuestro estilo” fue mezclado en formato normal y en Dolby Atmos , es decir, audio inmersivo. “Aquí, en la República Dominicana, los grupos de
salsa no lo han hecho. Van a tener la particularidad de poder escuchar los temas desde una perspectiva única, es como un surround o sonido envolvente pero mejorado, van a percibir que, a lo mejor en una canción, tienes el cantante aquí, pero Chiquito está allá atrás tocando y tú lo vas a sentir”, detalla el director musical.
Destaca además que esta es una de las tecnologías más prometedoras y “hacia allá va la música. Ya Spotify entró en eso”.
De modo que los que tienen un buen equipo de sonido en casa, estilo cine, o los amantes de los kitipó estarán en sus aguas con las canciones de este álbum en cuanto a la calidad sonora.
En la parte de los artistas, durante el encuentro con la prensa también hablaron de la selección de los cantantes para cada tema, y esta vez decidieron no solo estar al frente, sino como una orquesta en su conjunto.
“Si quieren escuchar “Perdóname” tendrán más conocimiento de quién la canta”, añade Frías.
Para el cofundador del grupo y timbalero Rafael Berroa (Chiquito Timbal), la clave para mantener la armonía en el grupo es la disciplina. ¿Hay rivalidad entre los

salseros? Los líderes del la banda respondieron que no, pero tampoco son cercanos. Ellos aseguran que invitaron a los salseros a esta actividad y no fueron.
No hay temas inéditos
La producción musical no tiene colaboraciones y tampoco hay canciones inéditas. En su defensa, Rafael Berroa reconoce que han compuesto canciones inéditas, pero lo que les ha funcionado son los covers “Nosotros tenemos en Youtube un track de una hora y media de temas inéditos, pero ¿qué sucede?, que cuando hemos trabajado temas inéditos hemos tenido que invertirle más, pero también a la gente le cuesta mucho más aceptarlos”, considera Chiquito. Para la próxima producción afirman que trabajarán en ello.
Apostando por la buena salsa y la calidad de las letras, los músicos expresaron que cada canción de este álbum ha sido creada con el objetivo de tocar el corazón de los seguidores de la música romántica. Luego de la debida pro-
“A nuestro estilo” (Álbum completo)
1. Porque será 2. Qué bello 3. Perdóname 4. Basta ya 5. Y llegaste tú 6. Detalles
7. No podrás 8. Si quieres
9. No te hago falta 10. No sé olvidar
11. Porque aún te amo
12. Otro día más sin verte
13. Llorando se fue
moción, Chiquito Team Band tiene planes de lanzar un próximo proyecto, pero de salsa pesada, destinado a los amantes del baile, regresando así al ritmo fuerte del grupo con temas especialmente diseñados para el disfrute de los bailadores.
“La llamada de mi ex”, “Tengo que colgar” y “Punto y aparte” son algunas de las canciones de la amplia discografía de los músicos dominicanos que en 2018 fueron nominados al Latin Grammy.
Con “A nuestro estilo”, su tercer álbum, la orquesta salsera “Chiquito Team Band” reafirma su posición como uno de los principales exponentes de la salsa dominicana. b
REVISTA 21 / Jueves, 9 de mayo de 2024 DiarioLibre.
Agenda
0 Enmanuel Frías y Rafael Berroa, líderes de Chiquito Team Band.
FÉLIX LEÓN/DIARIO LIBRE
“Don Quijote, el ballet” se presentará en junio en el TN
Los días del 7 al 9 reunirá a destacados artistas nacionales e internacionales
SD. Ballet Concierto Dominicano anunció la puesta en escena del espectáculo “Don Quijote, el ballet” del 7 al 9 de junio en el Teatro Nacional Eduardo Brito, a las 8:30 pm.
Destacadas figuras de la danza nacional e internacional participarán en el espectáculo, destacándose la presencia, como invitados especiales, del Ballet Nacional Dominicano, el primer bailarín Eliosmayquer Orozco y, del Spartanburg Ballet de los Estados Unidos, el primer bailarín Jonhal Fernández. La obra de Miguel de Cervantes contará con la dirección coreográfica del destacado maestro y coreógrafo Carlos Veitía, inspirada en la original de Marius Petipa, con música de Leon Minkus.
La escenografía estará a

Integrantes del espectáculo se reunieron con la prensa.
cargo de Fidel López, Lux Art y Junior Basurto operarán las luces, efectos especiales y sonido. Los visuales son de Makako Studio. El vestuario fue diseñado por Patricia Huerta, Sergia Arias, Mayeline Pérez, Germania Ozuna y Castia Fortuna. La utilería está a cargo de Víctor Datt y Elsa Pellerano. La regiduría de escena estará a cargo de Amaury Esquea, Yvette Pérez en gestión, Eli Rodríguez, el diseño gráfico, y William Guinand en maquillaje.
Los artistas del Ballet Concierto Dominicano, Karla Espaillat, Diana Dopico, Sander Roberts, Pedro Pablo Martínez, Anayilda Jáquez, Rissy De Los Santos, Lya Gómez, Oona García, y Luis Pérez, son algunos de los protagonistas del espectáculo.
Protagonistas
En los personajes de carácter, como Don Quijote de la Mancha, estarán el actor Miguel Lendor y en el papel de Sancho Panza Juan Rodríguez.

Leidsa entrega RD$120 millones a los ganadores 461 y 462 del Loto
SD. Leidsa informó que el joven José Ariel Contreras Santos y el señor Ramón Antonio Sánchez de La Rosa recibieron sus respectivos cheques de 60 millones cada uno.
Esa es la proporción que les corresponde por haber resultado ganadores de los 120 millones de pesos que tenía el acumulado del Loto, en el sorteo del pasado sábado 6 de abril.
José Ariel, empleado de una de las fábricas más grandes de embutidos del país, realizó una jugada seleccionada en Hoya Grande, Provincia La Vega, y tiene planeado instalar un

taller de electromecánica, labor que realiza en su tiempo libre.
Por su parte, Ramón Antonio, abogado en ejercicio,
que realizó una jugada automática en Los Jardines del Sur, Distrito Nacional, ampliará su bufete de abogados y planificará su retiro.
Grupo Hospifar celebra 30 años
SD. En el marco de su 30 aniversario, y durante una conferencia-cena titulada “Conectores ENFit para la reducción de riesgos en nutrición enteral”, el Grupo Hospifar, sus seguras opciones de salud y la empresa multinacional Cardinal Health, de la cual Hospifar es distribuidor en el país desde hace más de 15 años, lanzaron al mercado el Protocolo de Conectores ENFit.

Escape cultural
Jarouska Cocco
FIACI y el poder transformador del arte
Hoy empieza esta columna que invita a alejarnos un poco del bullicio a través del arte y la literatura. El arte nos inspira y transforma, y qué mejor motor para alimentar este nuevo espacio que la celebración en el país de la primera edición de FIACI, la Feria de Arte Contemporáneo. Su directora, Luz Botero, es curadora y galerista itinerante, lleva más de veinte años asistiendo a importantes ferias de arte del mundo, conectando con coleccionistas de todas las esferas e hilvanando ideas para una propuesta diferente.
Como resultado de ese andar surge la FIACI, un lugar donde se prioriza a los artistas y sus propuestas. El catálago es muy variado, artistas internacionales y nacionales, muchos consagrados y otros emergentes. Todos con un mismo hilo conductor, la maestría con que cada uno plasma su oficio. Las obras están expuestas concomitantemente en varios lugares como el Palacio de Bellas Artes, Museo de Arte Moderno, Centro Cultural Banreservas, Arte San Ramón y el Centro León en Santiago de los Caballeros. La feria presenta una curaduría donde las obras dialogan entre sí y, sobre todo, con el
espectador. También hay varios performances interactivos, como los del español Eugenio Ampudia, artista que duerme en diferentes lugares para habitarlos y recordarnos que cada espacio necesita de su tiempo, silencio y propia conversación. De igual modo, el colectivo urbano Boa Mistura con base en España, realizó un impresionante mural en la avenida Venezuela para promover la cultura en espacios públicos. Pero volvamos a esta iniciativa que se completa con un brazo social. La FIACI trajo consigo artesanas colombianas para capacitar mujeres privadas de libertad dentro del Centro de Corrección y Rehabilitación Najayo Mujeres, y que, con tan solo un mes de taller, les ha dado otra perspectiva de futuro a las internas. A la vez, su equipo de artesanas ha capacitado personas en Puerto Plata y Punta Cana. El resultado de esos trabajos está a la venta, son piezas bellísimas y la labor social que hay detrás es la que cuenta. La feria estará abierta hasta el 12 de mayo, es una experiencia visual, sensorial, enriquecedora y artística que vale la pena visitar. Esperemos que esta propuesta continúe expandiéndose, ganando un espacio en el mercado local y dentro de la región.
NoticiasOpinión Revista Deportes Jueves, 9 de mayo de 2024 DiarioLibre. 22 /
FUENTE EXTERNA
Federico Lebrón, Anallely Silva, Rafael Pérez Barroso, María Pérez y David Matta.
EXTERNA
FUENTE
NEAL CRUZ
José Ariel Contreras, Manuel Abreu y Ramón A. Sánchez.
Shakira, a un paso de zanjar líos en España
BARCELONA. Shakira está a un paso de zanjar sus cuentas pendientes con la justicia española, después de que la Fiscalía y las acusaciones hayan pedido el archivo de su segunda causa abierta por fraude fiscal, aunque la remiten a la vía administrativa para que salde sus deudas con Hacienda.
Según informaron fuentes jurídicas, la Fiscalía y las acusaciones particulares ejercidas por la Agencia Tributaria y por el gobierno regional de Cataluña (la Generalitat) apoyaron la petición de la defensa de que se archive la causa que la cantante tiene abierta por defraudar 6.6 millones de euros (unos 7 millones de dólares) en 2018, con lo que el juzgado no tendrá otra opción que cerrar el caso.

Shakira estaba acusada en España de fraude fiscal y debió pagar 6,6 millones de euros.
La defensa de Shakira pidió hace tres meses el archivo de la causa por fraude fiscal abierta contra la cantante, quien en agosto del año pasado ya depositó ante la Audiencia de Barcelona los 6.6 millones que le reclamaba Hacienda.
La Fiscalía se pronunció a favor del archivo, pero remitió a la cantante a la vía administrativa para que se ponga al día con Hacienda, de forma que la defensa destinará la suma inicialmente depositada en el juzgado a pagar la deuda que le reclama la Agencia Tributaria.
“Nos congratulamos de que la Fiscalía, por fin, se haya adherido a nuestra petición de archivo”, apuntó la defensa de la colombiana en un comunicado remitido a los medios. Fue precisamente la Fiscalía de Delitos Económicos la que presentó la segunda querella por fraude fiscal contra la cantante.
Dominicano Yasser Tejeda en Tiny Desk
NY. El cantautor dominicano Yasser Tejeda realizó una sesión en la plataforma Tiny Desk, ocasión en la que interpretó varios temas en compañía de sus músicos. “Esta ha sido una gran oportunidad para poder promocionar a través de esta gran plataforma lo
que estamos haciendo en la música”, dijo el artista al invitar al público a buscar el contenido en las redes sociales de Tiny Desk
“Yasser Tejeda es un talentoso guitarrista originario de la República Dominicana y graduado del aclamado Berklee College of Music.

Como se puede ver y escuchar en su participación en el Tiny Desk, Tejeda tiene la intención de aprovechar su herencia ancestral, sus estudios y su visión musical en su trabajo. Combina hábilmente la música tradicional dominicana con el jazz y el rock en presentaciones que mueven las caderas tanto como las mentes”, reseñó. Yasser Tejeda interpretó los temas “En el naranjo”, “Amor Congo”, “La vereda” o “Sarandunga”, entre otros.


Realizarán encuesta de consumo cultural
SD. El gobernador del Banco Central de la República Dominicana (BCRD), Héctor Valdez Albizu, y la ministra de Cultura, Milagros Germán, firmaron este martes un acuerdo interinstitucional para la realización de la Encuesta Nacional de Consumo Cultural (ENCC). El convenio, rubricado en el auditorio del BCRD, define un marco de colaboración que busca recopilar información cuantitativa y cualitativa sobre los hábitos culturales de la población, lo cual representa un paso importante hacia el fortalecimiento del sector cultural en la República Dominicana, y refleja el compromiso de ambas instituciones en procura de visibilizar el aporte económico de la cultura en el país.
Durante el acto el gobernador, Héctor Valdez Albizu, expresó que “esta encuesta, que llegará a 5,632 hogares de todo el territorio nacional, contribuirá a ampliar el horizonte de las actividades culturales, permitiendo, además, medir cuál es su peso específico en nuestra economía, resaltando hoy que el consumo en bienes y servicios culturales en los últimos cuatro años ha crecido al mismo ritmo que el producto interno bruto (PIB). Valdez Albizu afirmó que “durante el año 2010 el gasto en bienes y servicios culturales realizado en el país alcanzó el monto de RD$30,655.4 millones, lo que representa un 1.5 % del PIB de ese año. Cuatro años más tarde, el gasto en cultura asciende a 41,265.6 millones, para un aumento de RD$10,610.3 millones adicionales durante el periodo.
NoticiasOpinión Revista Deportes Jueves, 9 de mayo de 2024 DiarioLibre. / 23
Yasser Tejeda en el set.
Milagros Germán y Héctor Valdez Albizu.
Apto- Estudio amplio semi amueblado, bonita vista, pórton elect, 1parq.$14Mil. 809-565-0832
Plaza Libre
BELLA VISTA NORTE. Casi nuevo, amueblado, 5 aires, 3 habs, 2 1/2 baños, balcón, planta, 7mo piso, Rent: US$1,200. Sale: US$2,8000 Neg. Tel: 809 707 -1770
Aparta hotel Green House Zona Colonial, US$46 habitaciones full, Especial por mes RD$17mil con abanico. Apto.p/extranjero 1h. amueb con aire. RD$27,000. Especial de mes. 809-682-1111.
LAS CAOBAS, (EN TRANDO POR AV. MANO GUAYABO), 2do. Piso, 1par queo, balcón, sala-comedor, cocina, 2 dorms., 1 baño y área de lavado RD$16,000.00 INMUEBLES LP, 809-541-4837/809-3590812.
MIRADOR NORTE, (CERCA UNIV. 3RA. EDAD), 2do. Piso, 1 parqueo, balcón, salacomedor, cocina, 1 dorms., 1baño RD$18,000.00 INMUEBLES LP, 809-5414837/809-359-0812.
Exc. apto amueblado, prox. Colegio San Judas, 7mo piso, 2 h., 2.5 b., C/ Servicio, A/ Lavado, balcón, 2 parq. USD$1,300 Mantenimiento incluido. Inf.: 809-4816426.
DON BOSCO, (CERCA CARIBE TOURS), 3er. Piso, sala-cocina, 1 dorms., 1baño
RD$16,500.00 INMUEBLES LP, 809-541-4837/809-3590812.
Hermoso Apto. 2 hab., W/ closet, Jacuzzi, Amplio balcón y cocina, C/servicio, 107Mts2, 2 ascen., gimnasio, 2 parqueos. USD$220Mil. Tel: 809-7297533.
Vendo Apto. 138Mt2., 1 er piso, 2 Bñs., 3 Habs. Princi pal con su baño., C/servicio con su baño, A/Lavado., Sala, comedor, cocina, bal cón, 1Parqueo. Colinas de los Ríos. Cel:809-383-6884.
HOTEL CASA ALUGE ALQUILAMOS HABITACIONES ECONOMICAS, CONFORTABLES, C/SALOME UREÑA # 56. PARA RESERVACONES 809221-3891 DESAYUNO INCLUIDO.
Local comercial Delicias Maricris, 250 metros, en la Av. Francia numero 94, frente a UNIBE. Inf: Cristina Alvarez +1(829)-701-0802 / Nelson +1(829)-884-5620.
Afimar Apartamento entre Av. cayetano germosen y Av. Sánchez, Cerca Mirador Sur. Cont. 809-6963243
VENDO, hermoso Pent House, 3 nivel, 466Mts2, 3 habitaciones, 3 Baños, full todas las comodidades, frente al parque Mirador Sur, US$ 435, 000, Sr.Pérez 809-3033642.
Apto. Entrega en 3 meses, solo dos unidades nivel 3 y 4 144mts neto, 3hab..3.5 baños dos parqueos pre instalación para vehículos eléc tricos, área social, bbq, Jacussi, lobby climatizado, consulte precio. 809-8294047
Extranjero vende Apto NACO, por motivo de salud, 300 mt2, 3 Habs., 3.5 Bañs., Sala, comedor, biblioteca/officina con escalera corrediza, 2 balcones, 5 aires, cocina amplia con isla, área de lavado, cuarto de servicio. US$339,000 PRECIO NEGOCIABLE POR CONTRACTO RÁPIDO Whatsapp:809-446-0880
Exc. Ubicación. Bello apto, 140 mt2, 2 h., 2.5 Bñ, family, C/Servicio, A/Lavado, balcón, 2 parq., lokers y pisos en mármol. USD$260 Mil. Tel: 809-481-6426.
2 Habs., 2.5 baños, balcón, C/Servicio, 1 parq. techado, ascensor, planta, gas, seguridad. Tel: 809-844-2164.
Por la Jacobo Majluta, 3 habs., 2 Bñ, 1 parqueo. Y vendo rebolver Smith & Wesson corto. Tel: 809-9103404.
VENDO FINCA EN ARROYO FRIO CONSTANZA. De 36.091.48 tareas y bonba 3 pulgada diesel. Tel 809-530-5963/829-3437353
VENTA DE CASA O VENTA DE SOLAR CON 2,000 mt2 para construcción de 6 vivienda de 2niveles uni familiar, certificación de suelo y plan de suelo inclui dos. Precio US$2.3millones Neg. llarmar al 954-4493998. Sin Intermediarios
VENDO SOLAR en Pedro Brand, en un vacacional 10 Mil mtr2. Inf: 809-729-7658 / 809-621-0279
GRAN OFERTA VENDO LOCAL COMERCIAL Y APTO 180Mt2., Los Prados, Santo Domingo. Contacto Whatsapp: 809-953-7011.
Av. Nuñez de Cáceres #58, buen punto comercial, 105 mtr2, 2do nivel, 1 parqueo. Se reciben ofertas (Motivo de viaje). Tel: 809-5432959.
A domicilio reparamos lavadoras, secadoras y lava platos INVE RTER Especia lidad en diagnosticar fallas en equipos INVERTER Che queo gratis.Tel /W h a t s a pp 809-689-0467 / Cel.809441-4162.. AMAURYS.
A DOMICILIO REPARAMOS
Aire Acond., Neveras, lava doras, Secadoras, Estufas y Tarjetas electrónicas de equipos inverter. Chequeo Gratis.Trabajamos tambien los Domingo. 809-977-4016 WS. 809-385-3366
URB. LOS OLIMPOS, (en trando por Av. los Beisbolis tas, Manoguayabo), casa 2 pisos independientes, cada una con: galería, terraza, Sala, Comedor, Cocina, 3 dorms., 2 baños, 1er. Piso con marquesina RD$ 8.8 Millones INMUEBLES LP, 809541-4837/809-359-0812.
SE VENDE SOLAR, 1,662 MT2, Guavaberry Country Club , Manzana A, con vista al campo de golf, excelente ubicación, se permiten construir 2 viviendas. Precio US$162,500.00., Telf: 809820-7000
SOLAR DE 12,535Mt2., Al lado de Emotions By Hodelpa “camino de la playa” Inf:829-623-7591
VILLA AURA, (entrando por Av. los Beisbolistas, Manoguayabo), solar de 267.04 Mt2s., en excelente ubicación, Propio para Vivienda o Edificio, calles Asfaltadas y fácil acceso (US$85,000.00) INMUE BLES809-541-4837/809359-0812. Constanza. Se renta villa
Compramos todo tipo de obra de arte “CUADROS“, y vendemos, no importa la edad. y compramos excultu ras y no importa que tan vieja sea tambien lo com pramos. WS. 809-777-3010
PARA TI PENSIONADO(A)
Préstamos sin garantes, desembolso en 2 horas, con seguro de vida incluido y hasta 72 meses para pagar, no importa tu edad ni historial crediticio, Solicítalo Ahora, Llamadas y WhatsApp 809-472-0777
Atención: Préstamos con vehiculo y título de propie dad. Ven y compruébalo, No permitas que la financiera o el Bco. te quiten tu veh. desde 1% en adelante y si te lo quitan llámame, que lo refi nan ciamos o lo compra mos, No importa Cicla. Tel. 809777-3010

JUEVES 9 de Mayo de 2024 www.plazalibre.com
para Airbnb a 1,700 Mt snm. Con hermosas vistas. Cont: 809-696-3243 Vendo NISSAN SENTRA 2018 vers. USA, color GRIS, 665 mil TEL (829)929-1129 Informacion
Gredar
recién importado Excelentes Condiciones
Cabina Cerrado
al whts 973-4779374. Vendo
Caterpillar 12G
US$58,000
info. 829-222-4714.



































































Jueves, 9 de mayo de 2024 / PlazaLibre / 25
La Embajada del Japón Solicita persona para traba jar como Mayordomo en su residencia en Santo Domingo.Interesados favor enviar su CV con foto a: admnistracion@sd. mofa. go.jp Para más informa ción: https://www.do.embjapan.go.jp/ ( elegir versión en español)
FARMACIA EN STO. DGO. SOLICITA: MENSAJERO DELIVERY. Para trabajar en diferentes turnos, tener licencia de motor al día, papel de buena conducta, responsable y con deseos de trabajar. Interesados depositar C.V Av. Jose Contreras #140. Tel: 809-350-6893/ 829604-2852.
FARMACIA EN STO. DGO.
SOLICITA: CAJERO DESPACHADOR. Indispensable 1 año minimo de EXPERIENCIA PRACTICA en ventas de medicamentos y sistema de farmacia. Buen salario y ambiente de trabajo. Depositar su C.V Av. Jose Contreras #140. Tel: 809-3506893/ 829-604-2852.
AVISO DE CAMBIO DE COLOR. Del vehiculo de carga Marca Hyundai Modelo H-1, Año 2020 Color Blanco cambio a color Amarillo, Placa L410736, Chasis KMFWBX7HALU1 14612, a nombre de Cerveceria Nacional Domi nicana S A . RNC 101003723
AVISO DE CAMBIO DE COLOR. Del vehiculo de carga Marca International Modelo HV607, Año 2021 Color Blanco cambio a color Amarillo, Placa L443219 Chasis 3HAEJMMR6ML58 4413 a nombre de Cerveceria Nacional Domi nicana S A . RNC 101003723
AVISO DE CAMBIO DE COLOR. Del vehiculo de carga Marca Hyundai Modelo H-1, Año 2020 Color Blanco cambio a color Amarillo, Placa L410735, Chasis KMFWBX7HALU1 143291, a nombre de Cerveceria Nacional Domi nicana S A . RNC 101003723
AVISO DE CAMBIO DE COLOR. Del vehiculo de carga Marca SHINERAY Modelo X 30 CARGO VAN Año 2019 Color Blanco cambio a color Amarillo, Placa L412333 , Chasis LSYKFAAAGKG269263 , a nombre de Cerveceria Nacional Domi nicana S A . RNC 101003723
Coloque sus anuncios por teléfono SANTO DOMINGO
809-476-7000
Asistencia Adicional
809-947-5754/809-476-3002
Plazalibre.com
809-947-5754
Email: anunciatedl@diariolibre.com www.plazalibre.com
Horario
Lunes a Viernes de 8:30 am a 5:30 pm CIERRE PARA PUBLICAR
De Martes a Viernes el día antes, 12:00 pm. Para el Lunes: Viernes a las 3:00 pm.
Av. Buenaventura Freites 18, Jardines del Norte, Santo Domingo 10602
AVISO DE CAMBIO DE COLOR. Del vehiculo de carga Marca Hyundai Modelo H-1, Año 2020 Color Blanco cambio a color Amarillo, Placa L410734, Chasis KMFWBX7HALU11 2641 a nombre de Cerveceria Nacional Domi nicana S A . RNC 101003723
Se busca operario de máquina de costura industrial plana y/o merrow. Sector Don Bosco. Teléfono: (809) 984-2282.
Técnica en Terapia Física Se solicita técnica en tera pia física con experiencia y con capacidad de animar a grupos de personas mayores vacantevm@hotma il.com
Busco domestica de 25 a 40 años para vivir en casa de envejeciente, foto y datos al Wasap. 829-749-5050
Salón de Belleza solicita: Peluqueras y Manicuristas, buen salario. Tel:809-5655066 /Cel: 809-790-3383.
Empresa solicita Guardias de Seguridad para Santo Domingo Whatsapp 809-8202082
Se solicita Técnico Fumi gación, con o sin experien cia, 25 a 45 años, para hora rios diurnos y/o nocturnos certificado buena conducta, licencia al día, regalía sueldo a discutir, horas extras, seguro. Llamar 809-4124112 para citas. trulynolendominicana@ hotmail.com
AVISO DE PERDIDA DE MATRICULA .Del Vehiculo
Marca Changan Modelo
CS35 PLUS TURBO FWD, Año 2024, Color Blanco, Placa G651181, Chasis
LS5A3DKR9RA960971, a nombre de Plinio Omar Maceo Acevedo, Cedula 402-2638128-9
Perdida de matricula de la motocicleta marca SUPER GATO modelo BWS 150 año 2020 color ROJO placa K2213798 chasis LF3TCK CC1LB000167 propiedad de ERWIN IVAN GUZMAN GOMEZ CED. 031-0370770-3
AVISO POR PERDIDA DE MATRICULA del vehículo Jeep, marca: Land Rover, modelo: S.L.E, año: 1971, color: Verde, placa: G100392, chasis: 24443442H, a nombre de: PABLO MIESES VALERA, ced: 001-0870719-1.
Perdida de matricula del volteo marca DAIHATSU modelo V118LD-JU año 2002 color ROJO placa S006135 chasis V11863622 propiedad de SIMON TOMAS FERNANDEZ PICHAR DO CED. 031-0033169-7
CLASIFICADOS DE LÍNEAS
• Hasta 4 Líneas (RD$Día) Primer
• Más de 4 Líneas (RD$Día) Cada línea adicional hasta 12 líneas 12.70
• Destacados (RD$Día)
Negritas totales +15%
Fondo sombreado amarillo +30% Fondo sombreado otros colores +40% Marco +10%
• Legales Col
•
Perdida de matricula del automóvil privado marca TOYOTA modelo COROLLA CE año 1988 color ROJO VINO placa A296009 chasis JT2AE92E1J3080159 propiedad de RODOLFO ANTONIO CABRERA ALMO NTE CED. 031-0311800-0
Perdida de Matricula del AUTOMOVIL, Marca DAIHA TSU, Modelo MIRA ES, año 2018, Color BLANCO, Placa AA34013, Chasis LA360S 0010055, Propiedad de SANCHEZ OVALLES AUTO IMPORT SRL, RNC 1314130 82
Perdida de Matricula del JEEP, Marca TOYOTA, Modelo RAV 4 LE, año 2013, Color ROJO, Placa G455338, Chasis JTMZFREV3DD01 9266, Propiedad de JESUS MIGUEL PEÑA GENERE, CED. 40225235106
AVISO DE PERDIDA DE MATRICULA . Del vehiculo Marca Honda, Modelo FIT, Año 2012, Color Gris, Placa A774546, Chasis GE71505 5888, a nombre de Olga Lidia Garcia Paula, Cedula 40220108894
Perdida de Matricula , del AUTOMOVIL, Marca HYUNDAI, Modelo AVANTE, año 2012, Color BLANCO, Placa A665841, Chasis KMHDG41 LBCU289094, Propiedad de IVANA MARIA GUZMAN SALCEDO, CED. 40221913 011
Perdida de Matricula del Vehículo de Carga, Marca FORD, modelo F150 XL 4X4, año 2014, Color GRIS, Placa L392733, Chasis 1FTFW1EF7EFC57656, Propiedad de RODOLFO ANTONIO GUZMAN LARA, CED. 054001 20993
• Desplegados Col x modulo blanco y negro 505.00 Col x modulo full color 816.00
* Precios sin impuestos incluídos.
• Dónde publicar
Visitando nuestra oficina principal. Visitando nuestras agencias receptoras y puntos de recepción de anuncios. Llamando a nuestro call center para pago con tarjeta de crédito y/o transferencia bancaria.
• Como publicar más efectivamente
Identifique las características del producto. Publique sus anuncios dentro de una sección. Adicione resaltadores: negritas y colores. Identifique correctamente los teléfonos.
Políticas de Reposición:
Revise su anuncio el primer día de publicación, de necesitar correcciones puede llamarnos al 809-476-7000. Solo nos haremos responsables del primer anuncio incorrecto.
* Los anuncios publicados en Plaza Libre son responsabilidad exclusiva de nuestros anunciantes
NECESITO EMPLEADO (A) PARA BAR-RESTAURANT PARA CAJERA, CAMARERA Y COCINERO(A) CONOCIMIENTO EN EL AREA. TRAER CURRICULUM C/ SALOME UREÑA #56, ZONA COLONIAL. TEL. 809-221-3891.
Fabrica de Muebles Necesita URGENTE!! PINTORES con experiencia. Inf: 809598-6846 / 809-596-6879 / 849-352-9467.
Se necesita persona, preferiblemente pareja para atender finca de 28 tareas con piscina y casa en Haina (S.C). Vivienda y sueldo. Con o sin experiencia. Cel: 849-2453737 Whatsapp 347-4887307. Comunicarse con el Sr. Juan.
Contadora Administrativa Requisitos: Experiencia en dirección y coordinación contable Manejo de los ciclos contables Conoci miento reportes fiscales, Manejo TSS,Inclinada a resultados y crecimiento Mujer de hasta 55 años vacantevm@hotmail.com
Perdida de Matricula del JEEP, Marca HYUNDAI, modelo SANTA FE año 2014, Color BLANCO, Placa G329131, Chasis KMHST81C BEU294658, Propiedad de RODOLFO ANTONIO GUZMAN LARA, CED. 0540012 0993
PERDIDA DE MATRICULA DEL VEHICULO MARCA MITSUBISHI JEEP, PLACA G227099 CHASIS 4A4MN31S94E005963 A NOMBRE DE RAFAEL GARCIA LEONARDO
Perdida de Matricula del JEEP , Marca HYUNDAI, modelo TUCSON SEL 4X2, año 2018, Color PLATEADO, Placa G678225, Chasis KM8J33A42JU694811, Propiedad de CESAR AMADO GUZMAN UREÑA, CED. 05400600903
Agencias Receptoras
ZONA ORIENTAL Ens. Ozama Soler Group 809-598-2800
Charles de Gaulle Familia Jimenez & Asociados 809-414-8444 Inmobiliaria Grupo Master 809-483-1388
Lucerna Inversiones Taveras 809-596-4588 ext. 252
San Isidro (Urb. La Esperanza) Jiro's 809-596-4328
Los Prados Maxim´s Travel 809-227-8548
Bella Vista Publimaster 809-476-9223
Perdida de Matricula del Vehículo , Marca CHEVROLET, modelo CAMARO SS, año 2010, Color AMARILLO, Placa A703387, Chasis 2G1 FK1EJ8A9199939, Propiedad de LUIS NELSON SUAREZ ARIZA, CED. 0310480 5894
Perdida de Matricula del Vehiculo de Carga, Marca TOYOTA, modelo PICK UP, año 1985, Color AZUL, Placa L109182, Chasis JT4RN56 D0F0127310, Propiedad de WILSON JOSE POLANCO ANGELES, CED. 0540086 8096
Perdida de Matricula del Vehiculo de Carga, Marca TOYOTA, modelo TOWNA CE, año 2003, Color BLAN CO, Placa L258012, Chasis KM510066166, Propiedad de MAURICIO DIAZ PEÑA , CED. 05300197943
Gazcue Fergo Publicidad 809-689-2008 Luz Jacqueline 809-689-1115
Independencia (Zona Universitaria) Apices Inmobiliaria 809-412-8344
Honduras Lidissa Comercial 809-532-9912
Urb. Solimar Enma Peña 809-532-3743
SANTIAGO GCM Servicios publicitarios 809-894-2282 cel. 809-325-2520
de Recepción 809-333-2002/ 2003 MAIL BOXES ETC
26 / PlazaLibre / Jueves,
de mayo de 2024 Puntos
Naco,
1 ZONA ORIENTAL Megacentro, ext 2 MBE Charles de Gaulle, ext. 16 MBE Jumbo San Isidro, ext. 15 Gazcue, ext. 10 Jumbo Luperon, ext. 3 Piantini, ext. 4 La Julia, ext. 5 Sambil, ext. 7 Arroyo hondo, ext. 12 Rep. De Colombia, ext. 9 LA ROMANA/ Jumbo, ext. 6 PUNTA CANA/ Jumbo, ext. 13
9
ext.
día
publicación 203.00
de
x módulo 188.59
Clasidesplegados (1 columna hasta 13 módulos) Col x modulo Blanco y negro 492.00 Col x modulo Full Color 636.00
Perdida de Matricula del Vehiculo de Carga, Marca MACK, modelo CV713, año 2007, Color BLANCO, Placa L262302, Chasis 1M2AG1
1C37M066247, Propiedad de GRUPO SUPERALBA SRL,RNC 102020302
Perdida de matricula del JEEP marca MERCEDES BENZ modelo ML350 año 2007 color BLANCO placa G218727 chasis 4JGBB8 6E27A213181 propiedad de VANESSA DEL CARMEN ABINADER PEGUERO CED. 031-0333296-5
Perdida de Matricula del Vehiculo de Carga, Marca MACK, modelo CV713, año 2007, Color BLANCO, Placa L262301, Chasis 1M2AG11 C17M066246, Propiedad de GRUPO SUPERALBA SRL, RNC 102020302
Perdida de Matricula del JEEP, Marca HONDA, Modelo CRV EXL 4X4, año 2010, Color GRIS, Placa G350520, Chasis 5J6RE4
H74AL044157, Propiedad de OLIVER REYNOSO ACOS TA, CED. 40227289200
Perdida de placa del vehículo de carga marca TOYOTA modelo RN50L KRA año 1987 color AZUL placa L020790 chasis JT4RN5 0R5H0270499 propiedad de RAMON ACOSTA RODRIGUEZ CED. 092-00015452
Perdida de placa del automóvil privado marca TOYOTA modelo ACV30LAEPNKW año 2007 color BLANCO placa A475283 chasis JTNBE40K303089 530 propiedad de CRISTINO RODRIGUEZ PEÑA CED. 048-0059320-6
AVISO DE PERDIDA DE PLACA . Del vehiculo de carga Marca International Modelo 4300SBA, Año 2012, Color Amarillo, Placa L299278, Chasis 3HAMM AAR9CL547005, a nombre de Compañia Cerveceria Ambev Dominicana, RNC 101003723
AVISO POR PERDIDA DE PLACA de la motocicleta privada marca: KTM, modelo: Duke, año: 2018, color: Negro, placa: K1628639, chasis: VBKTU6407JM730365, a nombre de: ROBY MANUEL GENAO GOMEZ, ced: 402-3326814-9.
AVISO DE PERDIDA DE PLCA. Del vehiculo Marca Honda Modelo FIT HYBRID FWD, Año 2018, Color Plateado, Placa AA27149 Chasis GPS-1323773, a nombre de Min Motors SRL, RNC 1-31-173756
Perdida de placa del JEEP marca TOYOTA modelo 4RUNNER LIMITED 4X4 año 2011 color GRIS placa G340379 chasis JTEBUSJR0B5040717 propiedad de ADRIANO GIL CED. 031-0096925-6
Perdida de Placa N40 6670, de la Motocicleta, Marca PGO, año 2008, Color BLANCO, Chasis RFVC PCPC581009603, Propiedad de AUTO REPUESTOS LUCILO DOMINGUEZ SRL, RNC 109012538
AVISO POR PERDIDA DE PLACA de la motocicleta privada marca: Gato, modelo: CG150, año: 2017, color: Rojo, placa: K1123566, chasis: LRPRPJB06HA000055, a nombre de: FELIZ DOMINGO DURAN NUNEZ, ced: 056-0046831-7.
AVISO POR PERDIDA DE PLACA del vehículo Jeep, marca: Chevrolet, modelo: CK10706, año: 2007, color: Azul, placa: G153478, chasis: 1GNFK13J17J274124, a nombre de: JOSE APOLINAR DURAN NUNEZ, ced: 056-0046505-7.


Jueves, 9 de mayo de 2024 / PlazaLibre / 27

28 / PlazaLibre / Jueves, 9 de mayo de 2024
DEPORTES
Partidos con ventaja de 25 puntos o más han ganado los Boston Celtics en esta campaña, con su triunfo en el primer partido de la serie semifinal ante los Cleveland Cavaliers con marcador 12095, establecieron una marca para la liga incluyendo la postemporada.
Luiggy Chávez, el
CM
de
Juan Soto: “La idea es más importante que el vídeo”
El jardinero hace hincapié
en llegar a los fans Soto devengará US$3 millones por publicidad
Nathanael Pérez Neró Redactor Senior
SANTO DOMINGO. Hasta finales de 2021, el material que colgaba Juan Soto en sus redes sociales era aficionado; aquella foto o vídeo ocasional, sin retoques, de familia, junto a compañeros, en un estadio, con una personalidad que admiraba era lo que salía del móvil de la ya superestrella de los Nacionales. Lo que se sube desde entonces es material acabado, con edición de última generación y que alcanza millones de reproducciones.
Luiggy José Chávez, un egresado de multimedia del ITLA y que ha manejado la imagen en redes a políticos y empresas, entendía que Soto podía mejorar su perfil y utilizó una amiga en común para llegarle al jugador, al que convenció de trabajar para él tras varias conversaciones.
Chávez se convirtió en su Community Manager (CM), ese profesional responsable de construir y administrar la comunidad online y gestionar la identidad y la imagen de marca, creando y manteniendo relaciones estables con sus clientes y sus fans en internet.
Chávez viaja de Santo Domingo con frecuencia a los parques de las Grandes Ligas, recoge material exclusivo con cámaras y lentes que luego trabaja en su Mac con el programa DaVinci Resolve, donde asegura consigue mejores colores. Luego los discute junto a Natali, la hermana de Soto, que envía al pelotero. Este tiene la última palabra de lo

que se sube. Los peloteros no son el imán para los patrocinios como futbolistas o baloncestistas. Soto es el sexto en ingresos entre sus colegas por esa fuente este año (US$3 millones) según Sportico con marcas como Under Armour, Wilson, New Era y Topps. Fue el potencial que Chávez vio, aunque reconoce que al pelotero lo que más le convenció, tras un vídeo que le hizo en el Juego de Leyendas de Lidom en 2021, fue la oportunidad de llevar al fanático contenido de calidad exclusivo.
¿Qué le aporta un CM? “Pienso que manejo. Es mucho tratar de llevar la esencia del jugador a las redes sociales porque al final lo que la gente no ve es como si no se hiciera y al final tienes que vender tu fi-
Pues El Espía estuvo investigando sobre el tema de Félix Cabrera y resulta que sí hubo una respuesta de Lidom a su propuesta inicial, apenas cinco días después de hacerla y fue negativa. Lo que él espera es ver si uno de los interesados en montar el evento hacen otra propuesta para él tratar de igualarla. ¿Y si Lidom decide montar el show?
desaparecida escuela de arte Brothers y que la tatuó en su memoria. “La idea es más significativa que el mismo gran vídeo o gran foto. Lo más importante es saber qué quiere comunicar y cada cliente tiene objetivo distinto”.
“Cuando un cliente me busca tengo que hacerlo más grande, hacer que su figura resalte, en este caso Soto es una superestrella que tiene millones de seguidores y que, en teoría, no lo necesita, lo que hace mayor el trabajo”, dice Chávez.
Un caso especial
Pone el ejemplo de Jean Luis Rodríguez, director de Autoridad Portuaria, que lo contrató en 2020 al asumir al cargo y en su análisis identificó la necesidad de darse a conocer entre los jóvenes, por lo que la campaña tuvo que hacer hincapié en Tik Tok.

HA DICHO
“Tienes que comprar este PPV porque podría ser la última vez que veas pelear a Conor McGregor. Realmente creo que lo que le voy a hacer el 29 de junio garantizará que nunca regrese al octágono”
Michael Chandler Luchador de MMA
Línea de hit
Dionisio Soldevila
La sorpresa de Reynaldo López
El abridor de los Bravos coqueta con el liderato de efectividad de la Nacional
Si hay un pelotero dominicano que ha sido una sorpresa agradable para su equipo en la temporada del 2024, es el abridor de los Bravos de Atlanta, Reynaldo López, quien a la fecha coquetea con el liderato de efectividad de la Liga Nacional, solo detrás del japonés Shota Imanaga. Volviendo al rol de abridor, luego de haber perdido el puesto hace cinco años cuando se encontraba en Chicago, con los Medias Blancas, el petromacorisano solo ha subido al montículo comenzando juego... y le ha ido muy bien.
En sus seis aperturas del año, López tiene marca de 2-1 y 1.53 de efectividad, con 36 ponches y un WHIP de 1.13.
1,1
Millones de seguidores tiene Soto en su cuenta de Instagram, la mayor entre sus redes sociales.
gura. Eso al final puede ser dinero, que puedes presentar a las marcas”, dice Chávez, en visita a DL.
Soto ya supera los 1.1 millones de seguidores en Instagram, la red que más utiliza, y sus vídeos alcanzan cifras de siete dígitos en reproducciones.
Un vídeo durante el Clásico Mundial de Béisbol, en 2023, superó los dos millones de reproducción.
“La idea es mucho más importante que la pieza”, repite en la conversación Chávez esa oración de un creativo que escuchó en la
“Con Juan es diferente. Soto le llega a mucha gente, desde niños hasta personas mayores, aquí, en América Latina y Estados Unidos, el abanico del béisbol es muy amplio e Instagram es la red de más uso. Pero había mucho techo por crecer y seguimos desarrollando estrategias”, explica Chávez.
Un contenido que suele ir acompañado de música urbana, esa que el guardabosque de los Yanquis tanto consume.
Si bien Soto hace énfasis en la calidad y lo que pueda llevar al fanático, Chávez apunta a los números, al potencial que hay en las redes y lo que a futuro le puede aportar como instrumento de negocio.
“Más que todo siempre el crecimiento de esos numeritos, al final a eso es que se le podrá sacar provecho. Juan ve que es algo importante tener una red social funcionando, más que buscar el retorno. Es una herramienta. Le preocupa que el fanático esté al tanto. Pienso que él lo hace más por el lado del fanático”, dice Chávez. NPerez@diariolibre.com
La oposición apenas le está bateando .205 y solo ha tolerado dos cuadrangulares en las 35.1 entradas que ha lanzado en el año.
López está registrando el mejor inicio de temporada de su carrera de nueva campañas en las mayores... y de qué manera.
El quisqueyano ha sido clave para que los Bravos se mantengan pegados de los Filis de Filadelfia en la División Este de la Liga Nacional y en su última salida (el martes) lanzó cinco entradas y un tercio contra los Medias Rojas, permitiendo apenas una carrera limpia.
Junto a Charlie Morton, Chris Sale y Max Fried ha completado una rotación consistente y exitosa de los Bravos.
Toca esperar a ver si López puede mantener su consistencia la campaña completa o, por lo menos, una buena parte del año.
Breves
El jardinero dominicano Teoscar Hernández conectó ayer tarde su décimo cuadrangular de la temporada, tiene tres en la última semana de acción... Julio Rodríguez, de los Marineros de Seattle, batea .222, con un jonrón y solo cinco remolcadas en los últimos 15 días... El abridor dominicano Edward Cabrera fue colocado en la lista de lesionados por 15 días debido a una molestia en el hombro derecho. Originalmente se pensaba que era un tema en el bíceps... Juan Soto llegó a la jornada de ayer bateando .348 en el mes de mayo, sin haber sacado la bola del parque por primera vez este mes... José Ramírez tiene dos cuadrangulares en sus últimos siete juegos, pero apenas batea para .238 en la temporada... Muy feo lo que sucedió con Wirfin Obispo en México, suspensión por pelear con un fanático.
dsoldevila@diariolibre.com/ @dSoldevila en X (Twitter)
29 / Jueves, 9 de mayo de 2024 DiarioLibre.
LA CIFRA
EL ESPÍA
19
FUENTE EXTERNA
Luiggy José Chávez cubre a Soto desde finales de 2021.
Escogido y Estrellas intercambian jugadores en LIDOM
Los jugadores intercambiados tienen experiencia de Grandes Ligas
SD. Los Leones del Escogido y las Estrellas Orientales llegaron a un acuerdo para intercambiar jugadores en la pelota invernal dominicana.
El Escogido envió a las Estrellas al derecho Enoli Paredes a cambio del también lanzador derecho Domingo Acevedo.
Acevedo, de 30 años, actualmente lanza con los Charros de Jalisco en la Liga Mexicana de Béisbol, donde tiene marca de 1-0, 3.86 de efectividad, 0.85 de WHIP y cinco ponches en 4.2 episodios.
En la Liga de Béisbol Profesional de la República Dominicana, Acevedo totaliza 15 partidos y 25.2 entradas durante tres temporadas, incluyendo 1.40 de porcentaje de carreras limpias, 21 pon-

ches, récord de 1-0 y 0.86 de WHIP, el nativo de Villa Los Almácigos fue drafteado por el conjunto verde en la novena ronda del Sorteo de Novatos del 2016.
En su trayectoria, el serpentinero de 6’7” de estatura tiene experiencia de Grandes Ligas con los Atléticos de Oakland, lanzando para ese club entre el 2021 y el 2023 con registro de 4-4, 4.09 de efectividad, 1.11 de WHIP y 74 ponches en 88.0 capítulos, además de cuatro salvamentos.

Elly De La Cruz busca ser el octavo dominicano en liderar MLB en robos
Franklin Taveras fue el primero en lograrlo en la temporada 1977
Daniel Santana
SANTO DOMINGO. El electrizante corrido de bases de Elly De La Cruz con los Rojos de Cincinnati, y su agresividad para conseguir robarse las bases, tienen a muchos fanáticos del béisbol pensando en las posibilidades de que conquiste ese departamento en toda MLB. De La Cruz es el actual líder de todas las grandes ligas con 19, llevando una cómoda ventaja sobre su más cercano competidor. el venezolano Ronald Acuña Jr., quien cuenta con 14. Elly se robó 35 bases accionando en sólo 98 partidos el año pasado y Ronald Acuña Jr. se robó 73 almohadillas camino a conquistar el premio de Jugador Más Valioso de la Liga Nacional. Mientras que en la Liga
Americana, Esteury Ruiz lideró el circuito con 67, convirtiéndose así en apenas el quinto dominicano en liderar el encasillado, uniéndose a José Reyes (78), Juan Samuel (72), Franklin Taveras (77) y Willi Taveras (68). Taveras fue el pionero Franklin Taveras fue el primer dominicano en conseguir liderar ambas ligas en robos, lo logró en el 1977 con los Piratas de Pittsburgh consiguiendo 77 estafas, y superó a Freddie Patek (KC) que lideró la Liga Americana con 53. Luego hubo que esperar hasta 1995, para volver a ver un quisqueyano liderando todas las grandes ligas en ese renglón y fue Quilvio Veras con los Marlins de la Florida con 56, superando a Kenny Lofton (Cleveland) que tuvo 54. Tercero en la lista está Luis Castillo que lo consiguió en dos ocasiones, en el 2000 con 62, y en el 2002 con 48, superando ese año a su compatriota Alfonso

Soriano que con los Yankees, lideró la Liga Americana con 41. Unos años más tarde, vino el triple liderato de José Reyes en la nacional, en el 2005 lideró la nacional con 60, pero se quedó corto ante Chone Figgins (ANA) que terminó la temporada con 62, para que-
Béisbol, Récords y Vivencias
Bienvenido Rojas
darse con el liderato absoluto de MLB ese año.
“La Melaza” fue líder en el 2006 (64) y 2007 (78), marca para un dominicano, el quinto fue Willy Taveras en el 2008 (68), Adalberto Mondesí con 24 en el 2020 le siguió y el último fue Starling Marte con 47 para Oakland en el 2021.
Juan Soto es único, un superdotado sin comparación
“Tómame como el Tequila, de un golpe y sin pensarlo /Que si alguien sale ganando eres tú querida amiga/ Aunque pienses lo contrario” Ricardo Arjona
Juan Soto no necesita ser comparado con ningún jugador del pasado, ni del presente en las Grandes Ligas. Sencillamente, porque a la edad de 25 años y 197 días, ha demostrado en cada turno al bate con Juan es una guerra absoluta, porque tiene conciencia de la zona strike. Es una batalla ya sea en la primera o novena entrada y tu equipo gana por 10 carreras; todavía trata cada lanzamiento como si fuera el Juego 7 de la Serie Mundial. Soto ha demostrado que en cada juego impone un rasgo especial, que no necesita ser comparado ni con Ted Williams, ni con Albert Pujols y mucho menos con Ronald Acuña. Juan Soto, visto desde la numerología futurista de los Babalaos, cuando se suma lo que ha conseguido hasta la fecha, llegaría a los 36 años con una línea de .298/.428/.593, habrá pega-
do 2,317 hits, remolcado 1,996 vueltas y totalizado 91.1 WAR.
Lo citado en el párrafo anterior se denomina predicción o hipótesis sobre un proceso natural que se prevé que ocurrirá en el futuro basándose en teorías y observaciones previas. Se trata de una inferencia lógica basada en teorías de uso común y datos empíricos que pueden validarse mediante investigaciones adicionales u observaciones minuciosas. Archivemos esos números y recordemos que César Cedeño era tan bueno, tan emocionante, que los fanáticos de los Astros de Houston bautizaron el Astrodome como el “Palacio de César”. En un momento dado, el talento y la producción de Cedeño lo compararon con Willie Mays y Roberto Clemente. Bateó .310 a los 19 años. Lideró la Liga Nacional en dobles a los 20 años. A los 21 años bateó .320, lideró

la liga nuevamente en dobles, 22 jonrones, robó 55 bases y ganó el Guante de Oro. Leo Durocher, un gurú del negocio al inicio de la temporada de 1973, teniendo César 22 años expresó: “Cedeño es tan bueno o mejor que Willie Mays a la misma edad. No sé si puede continuar con esto durante 20 años, y no estoy diciendo que sea mejor que Mays. No hay forma de que nadie pueda ser mejor que Mays. Pero diré que este chico tiene la oportunidad de ser tan bueno. Y eso es decir mucho “. El 11 de diciembre de 1973, César, con 19 años, se fue con Altagracia de la Cruz (Malena) al motel “Keko” en
Santo Domingo y la mató de un tiro en la cabeza, hecho que calificado de “accidental” y fue acusado de homicidio involuntario, dejado en libertad tras pasar 20 días en la cárcel y el pago de $100 dólares de multa. Por ese motivo es que somos de opinión que a Juan Soto hay que analizarlo por su juego diario dentro de las líneas de cal, sin comparaciones futuristas. El béisbol no mantiene una lógica lineal, puedes batear .350 un año y al siguiente .270. Por eso hoy tomamos el modelo Cesar Cedeño que fue muy bueno y el sabermétrico Bill James, lo clasifica como el vigesimoprimer mejor jardinero central de todos los tiempos. Esa es una buena clasificación para cualquier pelotero, hasta para alguien quien se suponía debía ser el próximo Willie Mays. Juan Soto lo tiene todo, por eso no le pongo precio a su desempeño ni en Dólar, ni Morocota.
Twitter: @bienvenidorv brojas@diariolibre.com
NoticiasOpiniónRevista Deportes Jueves, 9 de mayo de 2024 DiarioLibre. 30 /
Juan Soto
Elly de la Cruz está líder en bases robadas en MLB con 19.
DOSTER
AP/AARON
Domingo Acevedo
Las 12 Reinas del Caribe para París 2024 se definen en junio
El equipo será escogido al finalizar el Final Six que se jugará en RD
Carlos Sánchez G.
SD. Como fuerte será el torneo de voleibol femenino de los Juegos Olímpicos para la selección nacional femenina, de igual manera también será el convertirse en una de las 12 Reinas del Caribe que vestirán el uniforme tricolor.
Y se trata de un proceso, también exigente para las jugadoras.
El próximo compromiso de la selección será la Liga de Naciones (LN) que va de mayo 14 a junio 23. Será la primera vara de medida.
El calendario de competencia de los Juegos Olímpicos será anunciado después de los Juegos Olímpicos, ya que restan cuatro equipos por clasificar y saldrán de la LN, dijo el director de Selecciones Nacionales Femeninas de voleibol, Cristóbal Marte.
La selección viajó a Brasil, donde llegó con un grupo en el que pueden tomar parte 14 jugadoras, pero para las Olimpíadas serán 12 jugadoras.
Esta será la primera fase evaluatoria para definir las 12 jugadoras con derecho a vestir el uniforme tricolor en París.
El equipo nacional com-
WNBA

petirá en la pata de Brasil, semana 1, donde enfrentará a Serbia (15 de mayo); Canadá (16); Corea del Sur (18) y Estados Unidos (19).
La semana 2 será en Macau, China y la semana 3, en Hong Kong. En esa etapa deberán conocer si avanzarán a la final por primera vez en esta Liga.
Finalizado este campeonato, entonces regresan para competir en el Final Six, en República Dominicana, sede del campeonato. “Después del Final Six
ahí tendremos el equipo”, señala Kwiek.
En la LN se permiten hasta 14 jugadoras, pero esto en nada significan que de ahí se escojan las 12 olímpicas. “Posiblemente no, porque Brenda (Castillo) no asiste a Liga de Naciones porque tiene compromiso hasta el 5, igual que Bethania (de la Cruz) que tiene compromiso en Estados Unidos y no va a estar”, señala Kwiek.
Una vez se juegue y finalice el Final Six “ahí se defi-
nen las 12”.
La selección dominicana, que partió el viernes, se encuentra en Brasil en una base de entrenamientos.
En la Liga de Naciones
Las jugadoras que competirán en la Liga de Naciones son Brayelin Martínez (opuesta/salida); Gaila González (opuesta); Larismer Martínez (libero); Yaneiry Durán (libero); Brenda Castillo (libero); Cándida Arias (central); Yineiry Martínez (central); Lisvel Eve Mejía (central); Geraldine González (central); Vielka Peralta (opuesta/salida); Yonkaira Peña Isabel (salida); Alondra Tapia (opuesta/salida); Niverka Marte (acomodadora); Ariana Rodríguez Fong (acomodadora); Madeline Guillén Paredes (salida) y Bethania de la Cruz de Peña (salida).
Castillo y De la Cruz se unirán después al equipo. Brenda finalizó como subcampeona en la Champions League al caer su equipo Allianz Vero Volley Milano en cinco sets ante el A. Carraro Imoco Conegliano 3-2 (25-14, 23-25, 25-19, 19-25, 15-9). De la Cruz juega en Estados Unidos con el Omaha Supernovas.b
comenzará vuelos chárter de tiempo completo;
Basado en un pacto de US$50 millones por las próximas dos temporadas
ESTADOS UNIDOS. La WNBA planea comprometer $50 millones de dólares durante los próximos dos años para brindar servicios de vuelos chárter de tiempo completo para sus equipos durante la temporada, anunció el martes la comisionada de la liga en una medida que aborda años de preocupaciones sobre la seguridad de las jugadoras. La comisionada Cathy Engelbert dijo en una reunión con editores deportivos que la liga lanzará un programa chárter “tan pronto como podamos tener aviones en los lugares”. Dijo que se prevé que cueste alrededor de

El Madrid lo hizo de nuevo y pasa a final Champions
El onceno blanco tumbó al Bayern y se las verá con el Dortmund
MADRID. Con otra remontada cuando parecía desahuciado, el Real Madrid doblegó 2-1 al Bayern Múnich y se clasificó a la final de la Liga de Campeones por tercera vez seguida. Joselu anotó a los 88 minutos y luego en el tiempo de descuento para que el conjunto español — dueño del récord con su 14 títulos en la Copa de Europa — se impusiera 4-3 en el marcador global y citarse con el Borussia Dortmund en la final del 1 de junio en Londres.
un privilegio nivel NBA
25 millones de dólares al año durante las próximas dos temporadas.
Eso significa que no habrá más largas filas de seguridad, guardaespaldas en espacios públicos, espacio reducido para las piernas o escalas para los atletas profesionales que han estado presionando para mejorar los viajes mucho antes de que la celebridad de Caitlin Clark despertara el interés en la liga.
Lo más importante, dice la delantera del Lynx de Minnesota, Napheesa Collier, es que significa seguridad para las jugadoras. “Todas estas jugadoras y estas caras se están volviendo tan populares que realmente se trata tanto de eso como de recuperación”, dijo Collier, señalando cómo la temporada pasada

Brittney Griner fue acosada para lo que la WNBA llamó un “provocador” mientras viajaba comercialmente. La WNBA nunca ha sido más popular gracias a novatas como Clark, quien ayudó a la NCAA a alcanzar su mejor audiencia en la historia para el baloncesto femenino, con casi 19 millones
de fanáticos viendo el juego por el título, junto con Angel Reese, quien asistió a la Met Gala el lunes por la noche y Cameron Brink. Engelbert dijo en ese momento que la liga necesitaba estar en la posición financiera adecuada para realizar vuelos cárter de tiempo completo. b AP
El Bayern se puso en ventaja a los 68 minutos mediante el gol del zaguero canadiense Alphonso Davies. La primera anotación de Joselu fue un sutil taquito, luego que el portero del Bayern Manuel Neuer dejó un rebote tras un remate no muy exigente. El segundo tanto fue anulado en primera instancia por una posición adelantada pero eventualmente decretado como válido tras la intervención del videoarbitraje. El Madrid acudirá a su 18va final del máximo torneo de clubes de Europa, un récord. Será su novena final en la era de la Liga de Campeones, otro récord. bAP
Jokić es elegido el MVP de la NBA por tercera ocasión
El centro serbio recibió 79 de los 99 votos para el primer lugar
NY. Nikola Jokić se apoderó otra vez del trofeo al Jugador Más Valioso de la NBA. El astro serbio de los Nuggets de Denver fue anunciado el miércoles como ganador del premio –su tercero en las últimas cuatro campañas, una proeza que sólo seis jugadores más han conseguido.
Jokić promedió 26,4 puntos, 12,4 rebotes y 9 asistencias. Otros tuvieron mejores promedios en cada categoría --y Jokić ha tenido mejores
años en todas--, pero el balcánico fue el único en figurar entre los 10 mejores de la NBA en los rubros de puntos, rebotes y asistencias en esta temporada. Recibió 79 de un máximo posible de 99 votos a primer lugar de parte de un panel de reporteros de medios, quienes se pronunciaron una vez que concluyó la temporada regular. El canadiense Shai Gilgeous-Alexander, de Oklahoma City, fue segundo, mientras que el esloveno Luka Dončić se ubicó en el tercer sitio. Ambos se situaron entre los tres más votados para el galardón por primera vez. b
NoticiasOpiniónRevista Deportes Jueves, 9 de mayo de 2024 DiarioLibre. / 31
FIVB
Marcos Kwiek anunciará las 12 de París 2024 el mes próximo.
AP/JOSÉBRETÓN
Joselu celebra tras anotar el segundo del Real Madrid.
AP/JOHNLOCHER
Los encargados de equipaje de las New York Liberty cargan bolsas en autobuses en el Aeropuerto Harry Reid.
De buena tinta
Las inundaciones urbanas de la capital
Pavor cuando llueve en Santo Domingo
Sí, sabemos que la República Dominicana es uno de los países que más podría afectar el cambio climático y, en los últimos dos noviembres, hemos sufrido en carne propia cómo aguaceros torrenciales convirtieron a la Primada de América en una nueva Venecia.
Y las lluvias cayeron de nuevo, el
Protagonista del día
 Pablo Ulloa
Pablo Ulloa
Defensor del Pueblo
El trabajo del funcionario público independiente en las negociaciones entre el Ministerio de Educación y la Asociación Dominicana de Profesores lo ha hecho destacarse por el buen desenvolvimiento y la ayuda para resolver el impasse.
QUÉ COSAS
martes y el miércoles, provocando lo que ahora se llaman “inundaciones urbanas”, pasos a desnivel y túneles rebozados un par de pies por encima del nivel del piso. Poco se explica que ni el Instituto Nacional de Tránsito ni tampoco el Ministerio de Obras Públicas tomen las previsiones de cerrar el paso de los cruces llenos de agua (¿olvidaron lo que pasó en la intersección de las avenidas 27 de Febrero y Máximo Gómez hace solo seis meses?).
Veneno de sapo ayuda con depresión
MADRID El veneno del sapo del Desierto de Sonora contiene un psicodélico que, convenientemente modificado, podría ser una opción terapéutica eficaz contra la depresión y la ansiedad, según un estudio realizado en ratones. La investigación se centra en el mecanismo por el que el alucinógeno 5-MeO-DMT interactúa con un receptor de serotonina llamado 5-HT1A. EFE
Moscú: Insólita nevada primaveral
MOSCÚ La capital rusa registró una inusual nevada para esta época del año que dejó un manto blanco sobre la ciudad en vísperas del Día de la Victoria sobre la Alemania nazi, la festividad más importante en este país. Los servicios meteorológicos destacaron que Moscú registra en estos días las temperaturas más bajas desde finales del siglo pasado (1999). EFE
Estrenan
Pero no todo puede cargársele a las autoridades. ¿Por qué usted chofer y ciudadano/a pone en riesgo su vida de esa manera?
Mientras tanto, las previsiones por los aguaceros no incluyen limpiar los bornales, mucho menos hablar de comenzar los trabajos harto prometidos de un nuevo sistema de drenaje. Hasta la zona colonial sufrió inundaciones por primera vez en casi 600 años. ¿Se salva alguien? b
duchas para perros
SALAMANCA El Ayuntamiento de Salamanca ha instalado duchas para perros en tres zonas destinadas para las mascotas, un sistema que consta de un aro con difusores que pulverizan agua, de manera que “se economiza el consumo de agua” y al mismo tiempo “se promueve el correcto uso de las zonas para perros, evitando la errónea utilización de fuentes y estanques”. AGENCIAS
Nueva terapia en tumores sólidos
NUEVA YORK La terapia celular CAR-T es cada día más usada contra los cánceres de la sangre y un equipo ha probado ahora, con ratones, una adaptación para tratar además tumores sólidos, un avance que podría transformar el tratamiento de esa enfermedad. El estudio hecho por Investigadores de la Facultad de Medicina Albert Einstein fue publicado en Science Advances. EFE

JUEVES, 9 de mayo de 2024
ARCHIVO

Francelys Furcal
Francelys Furcal






















































 Pablo Ulloa
Pablo Ulloa
